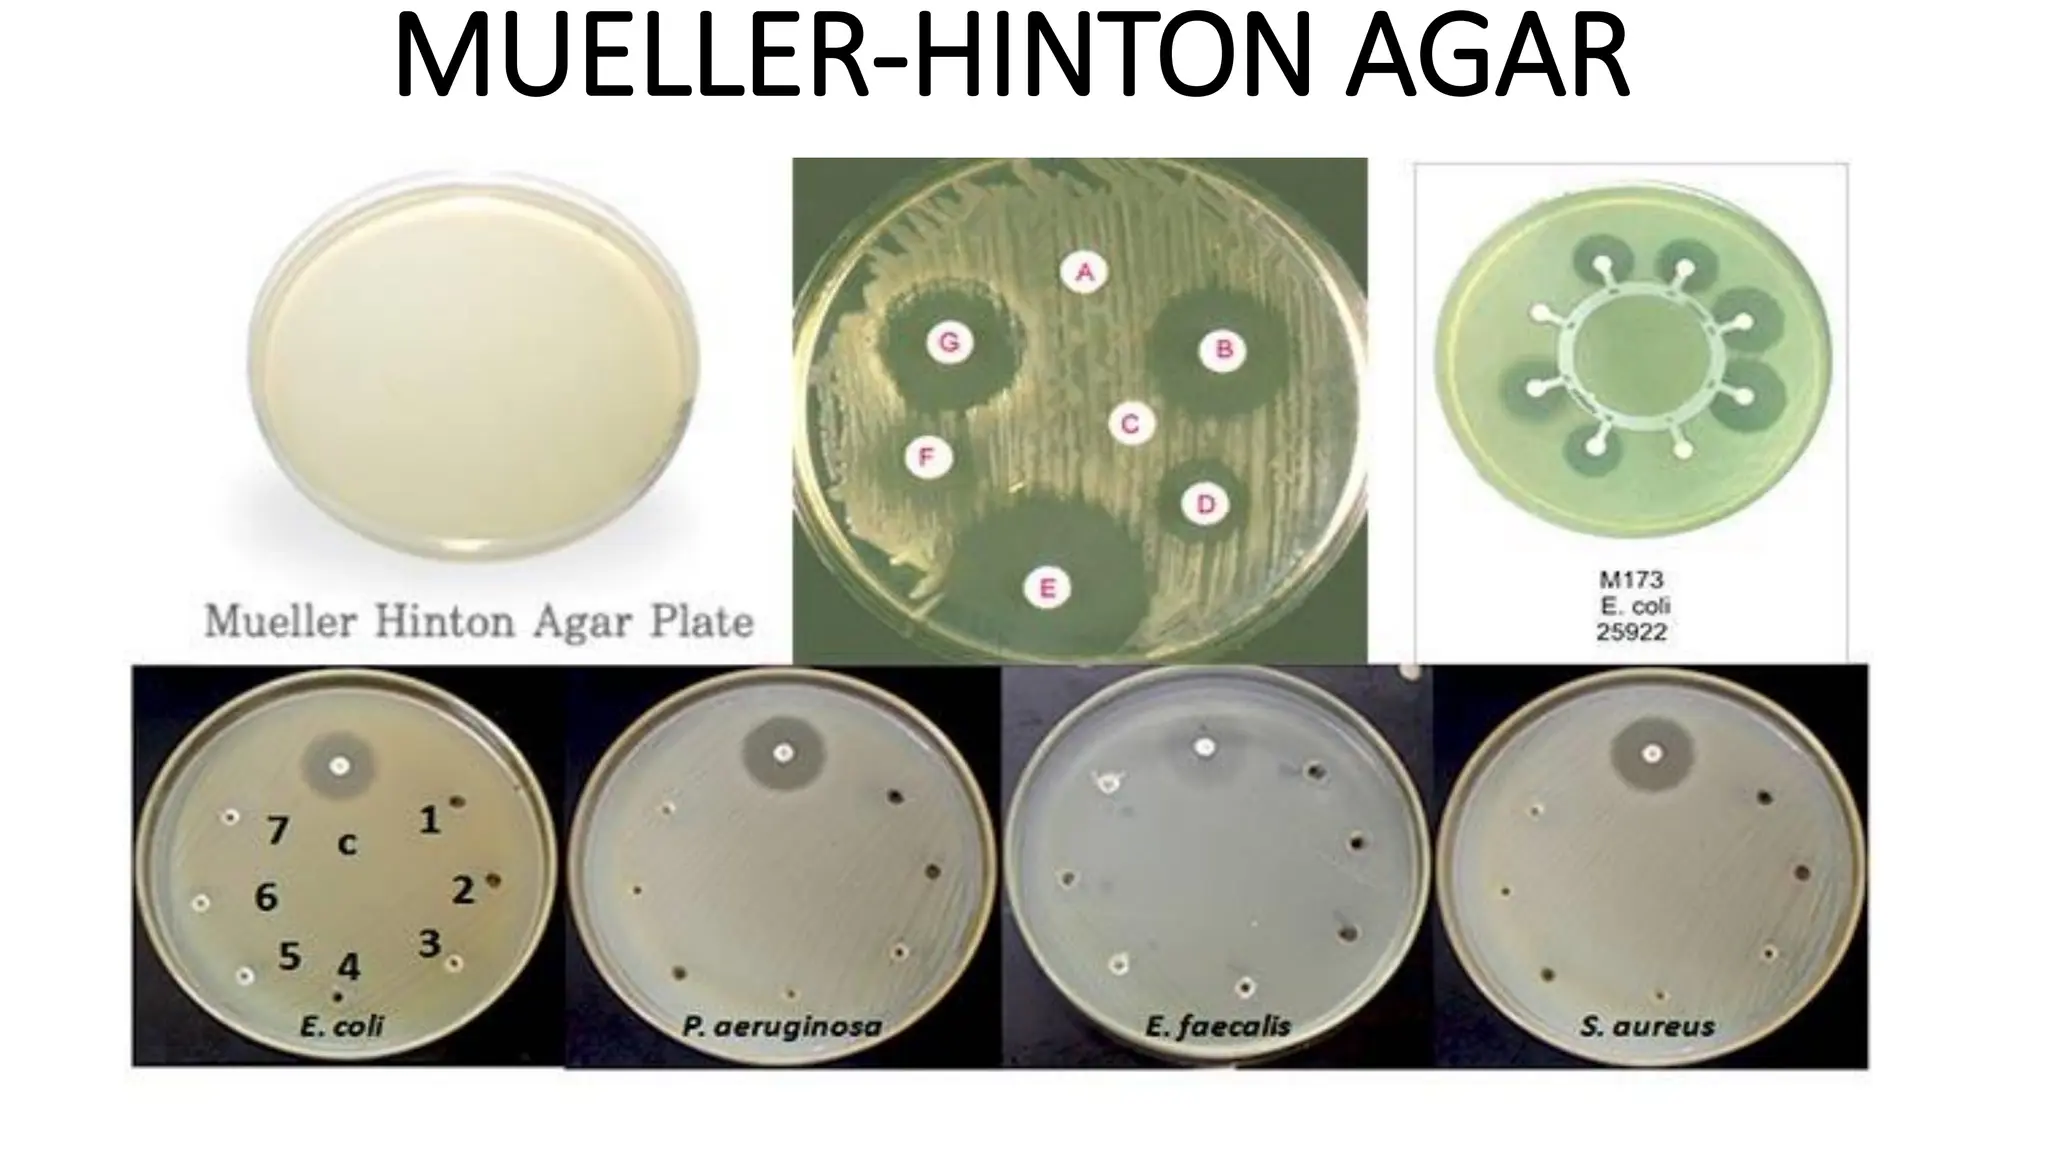
MUELLER-HINTON AGAR
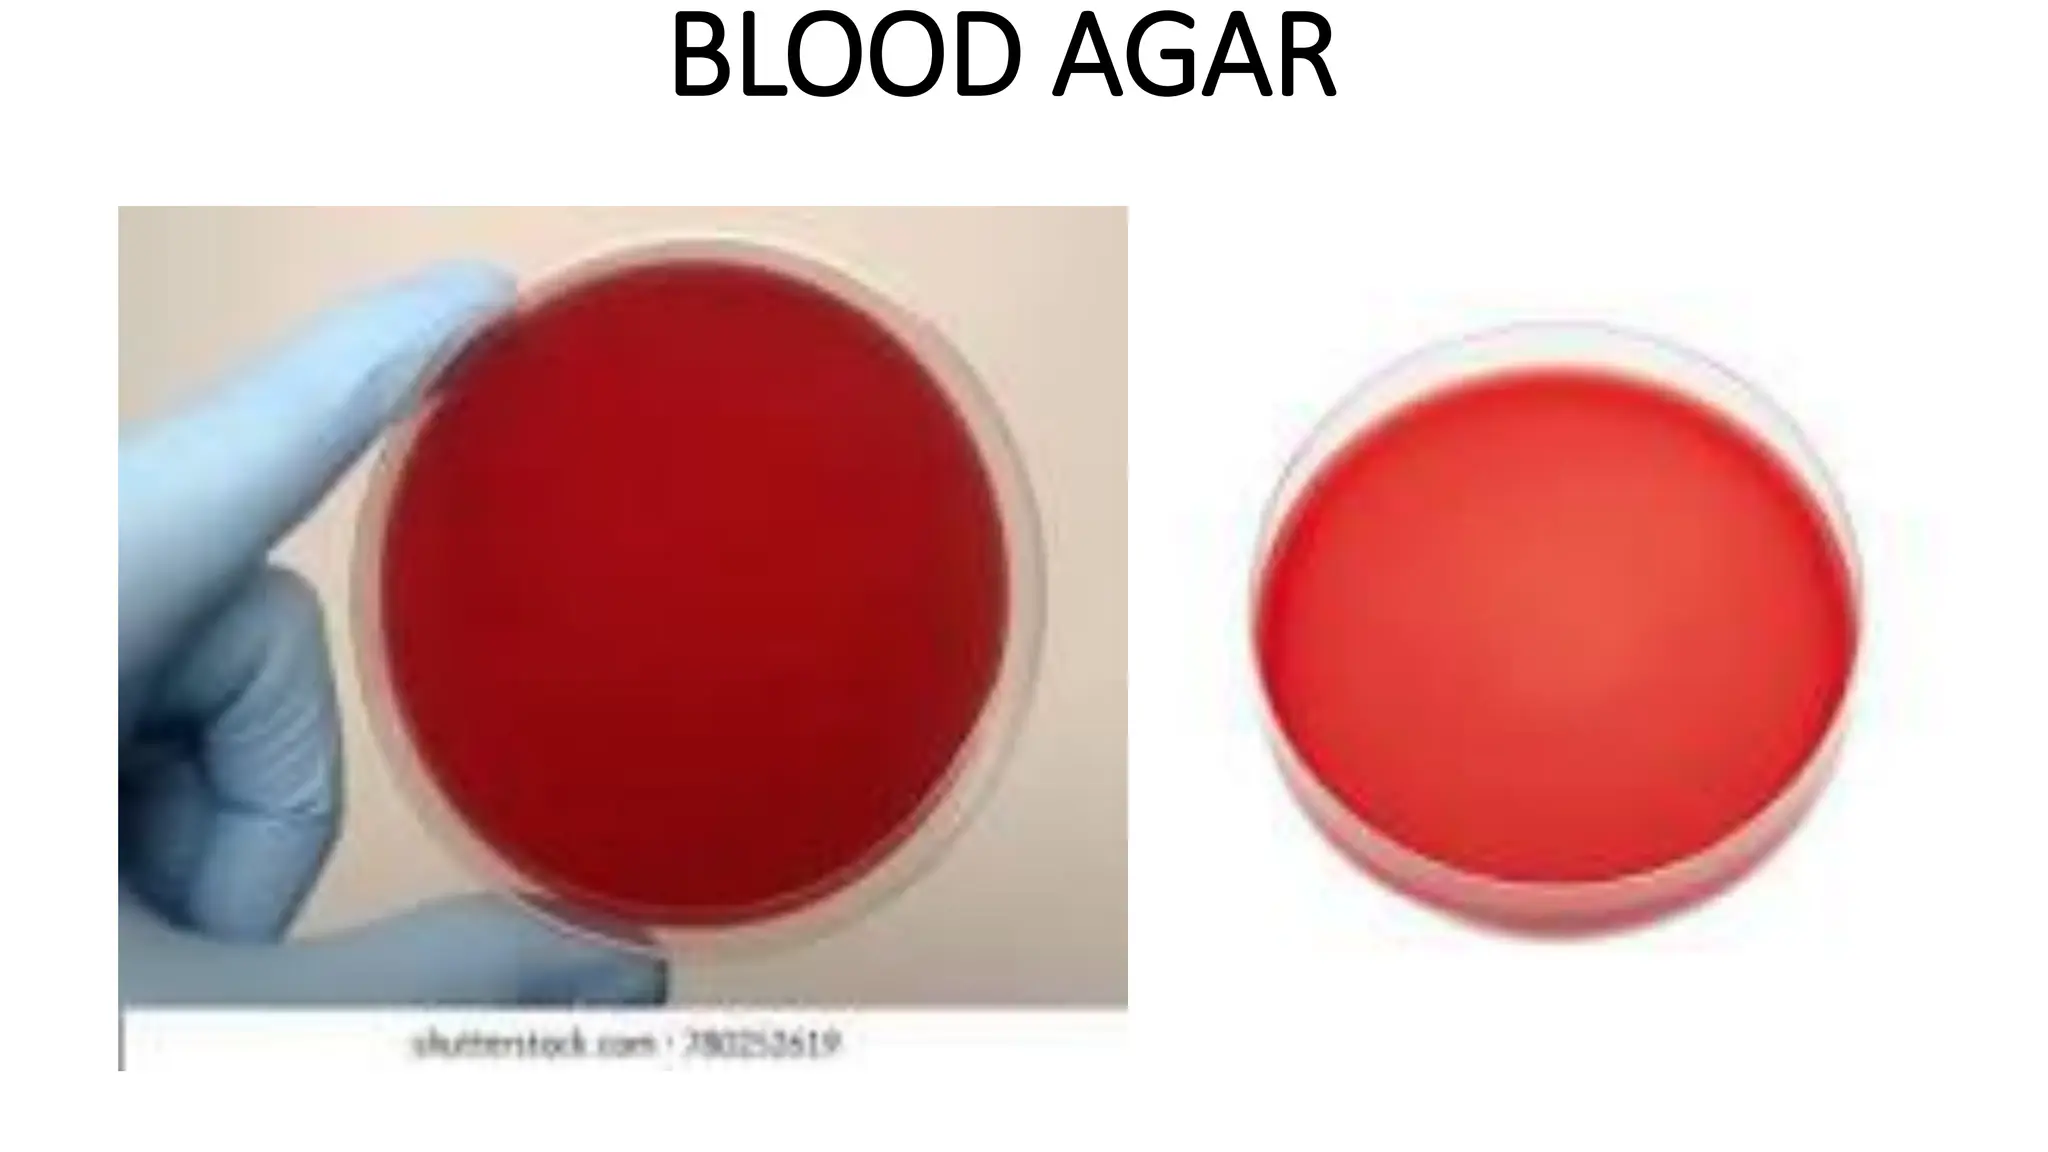
BLOOD AGAR
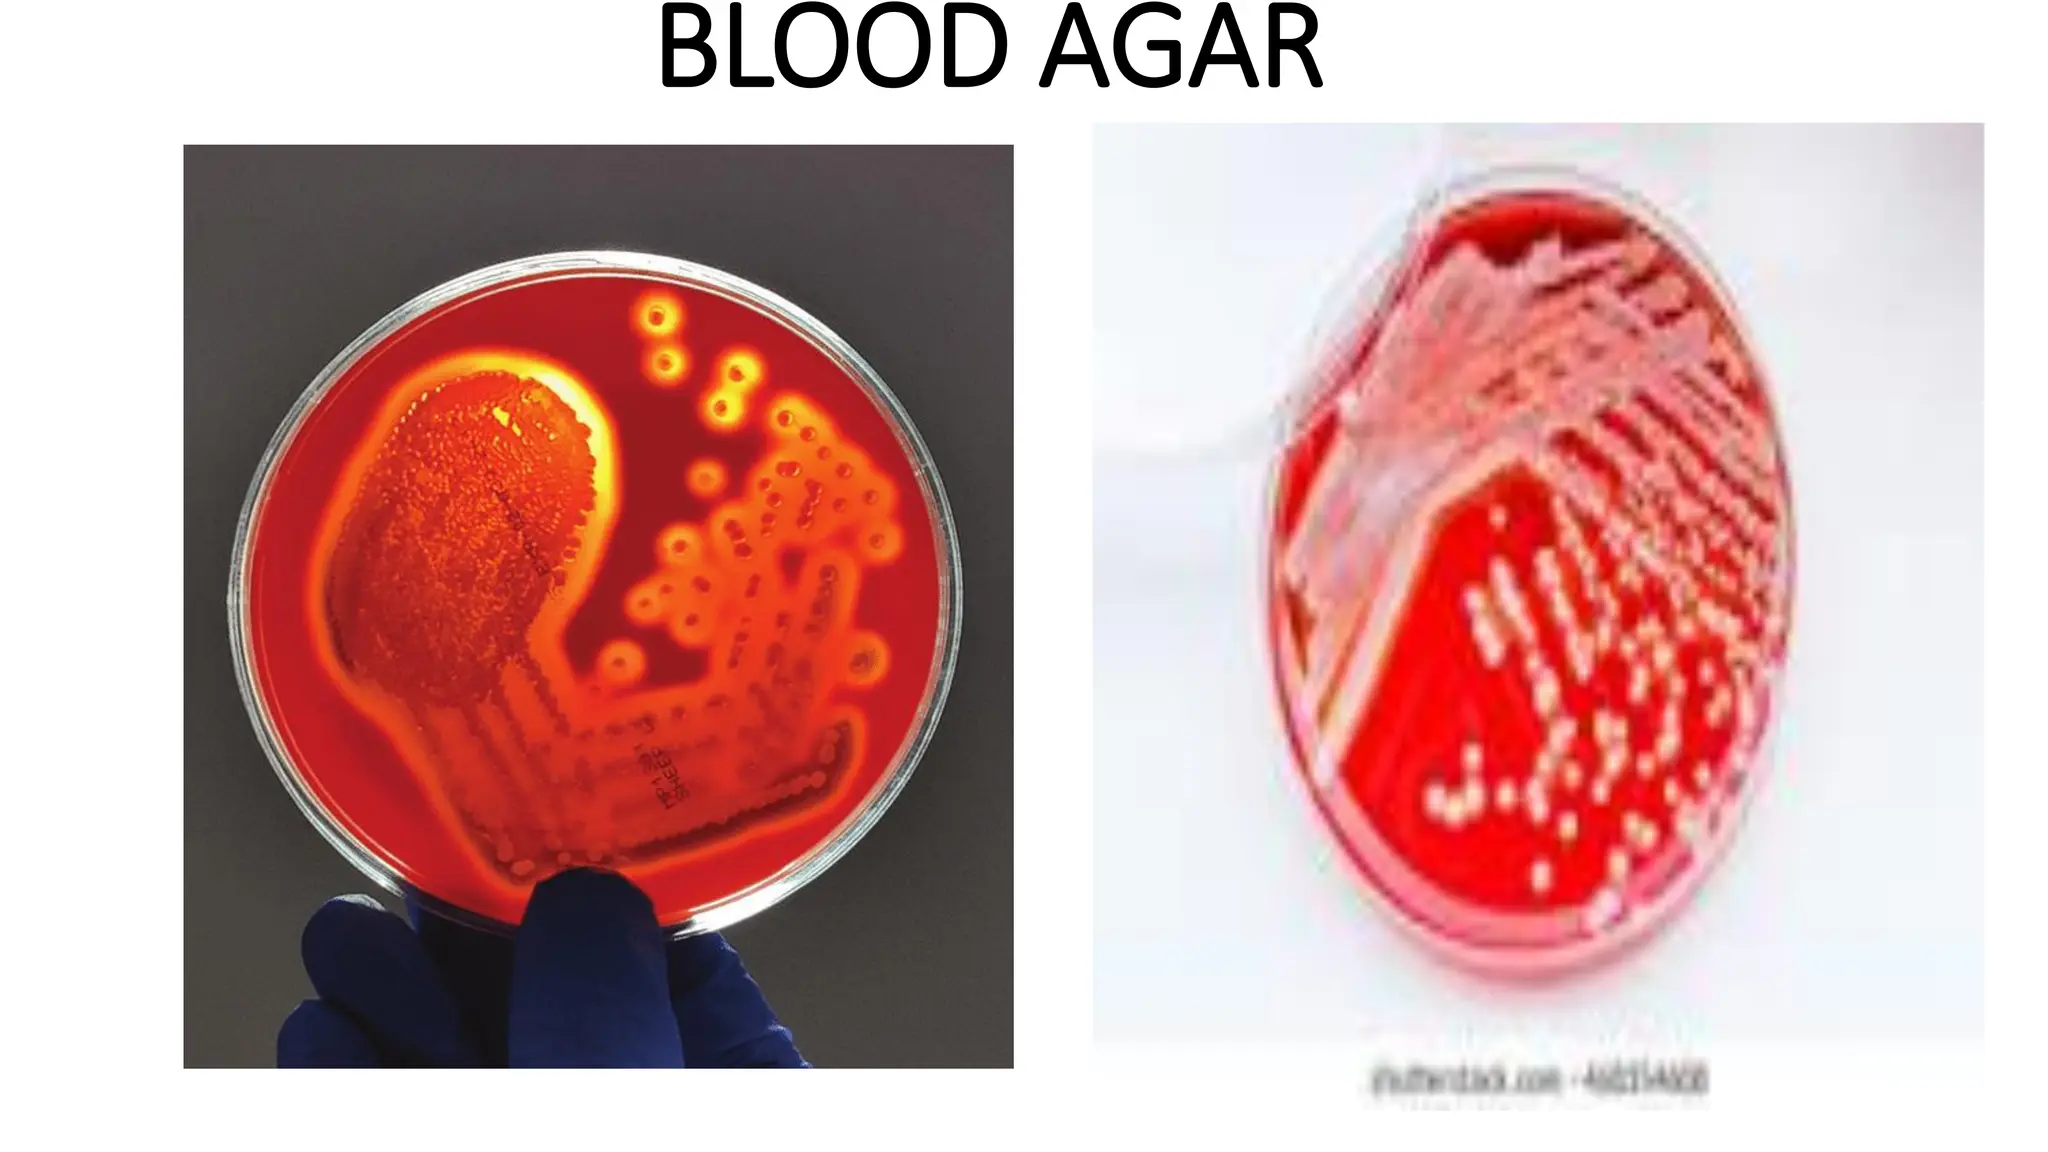
BLOOD AGAR
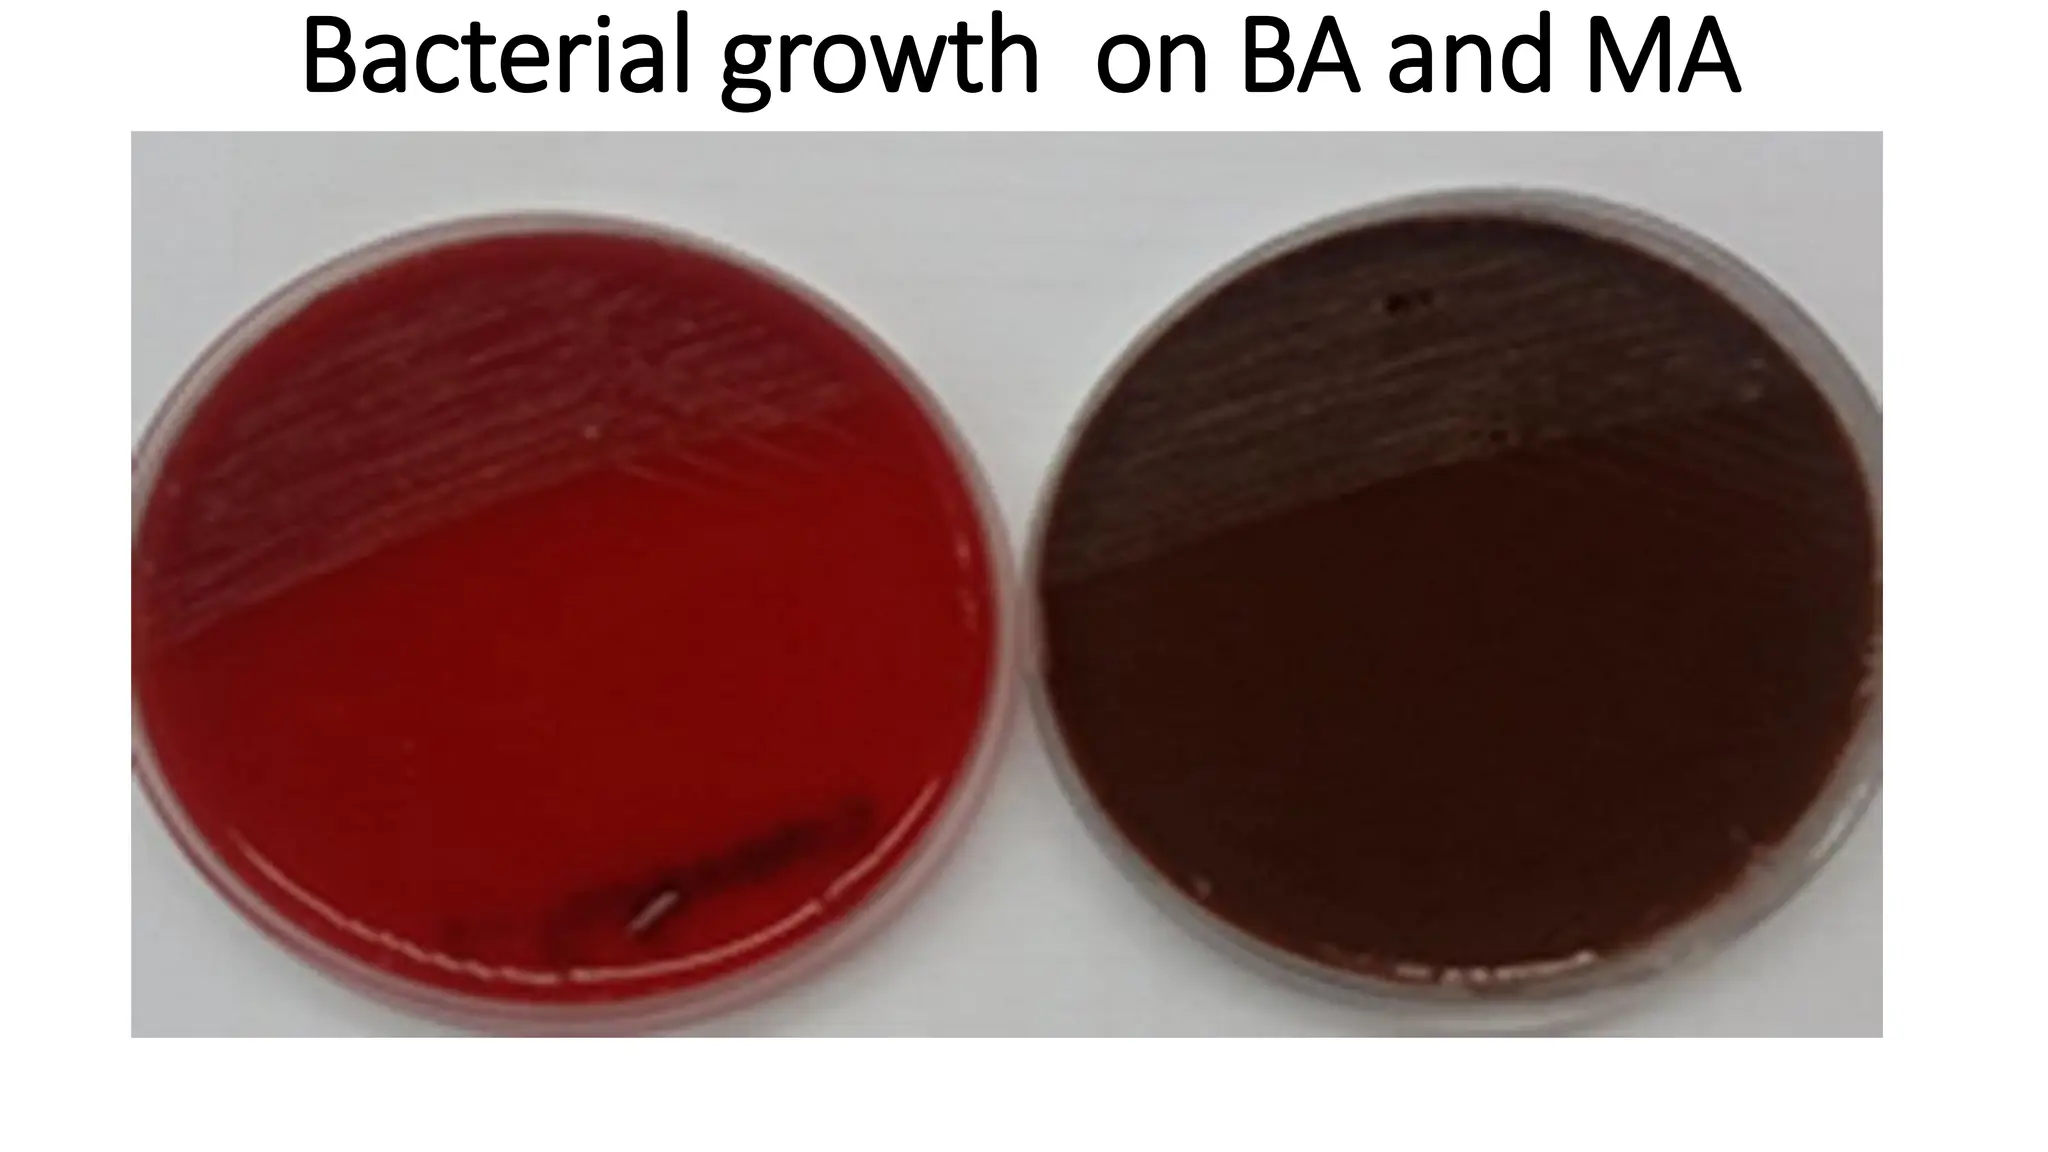
Bacterial growth on BA and MA
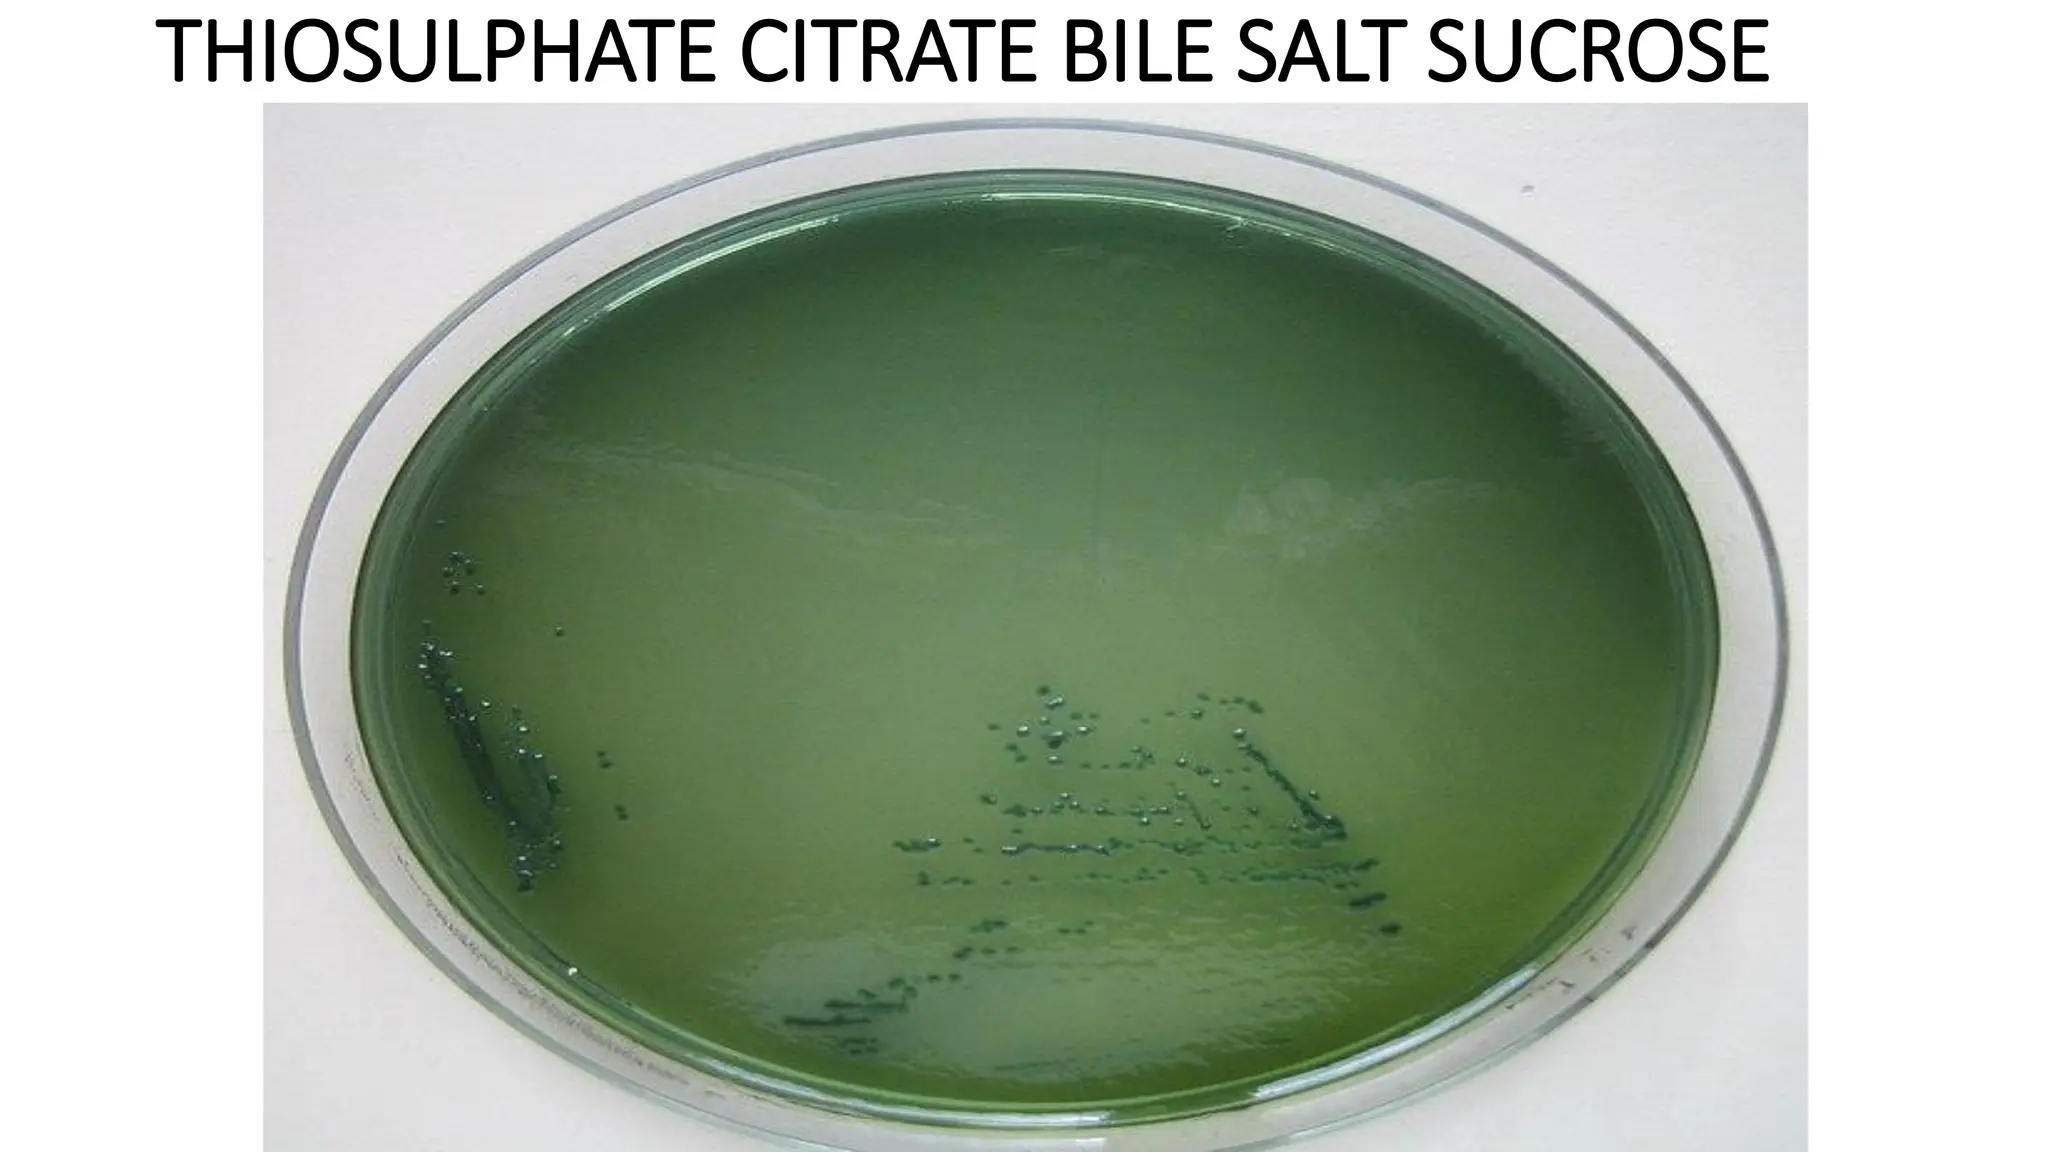
THIOSULPHATE CITRATE BILE SALT SUCROSE
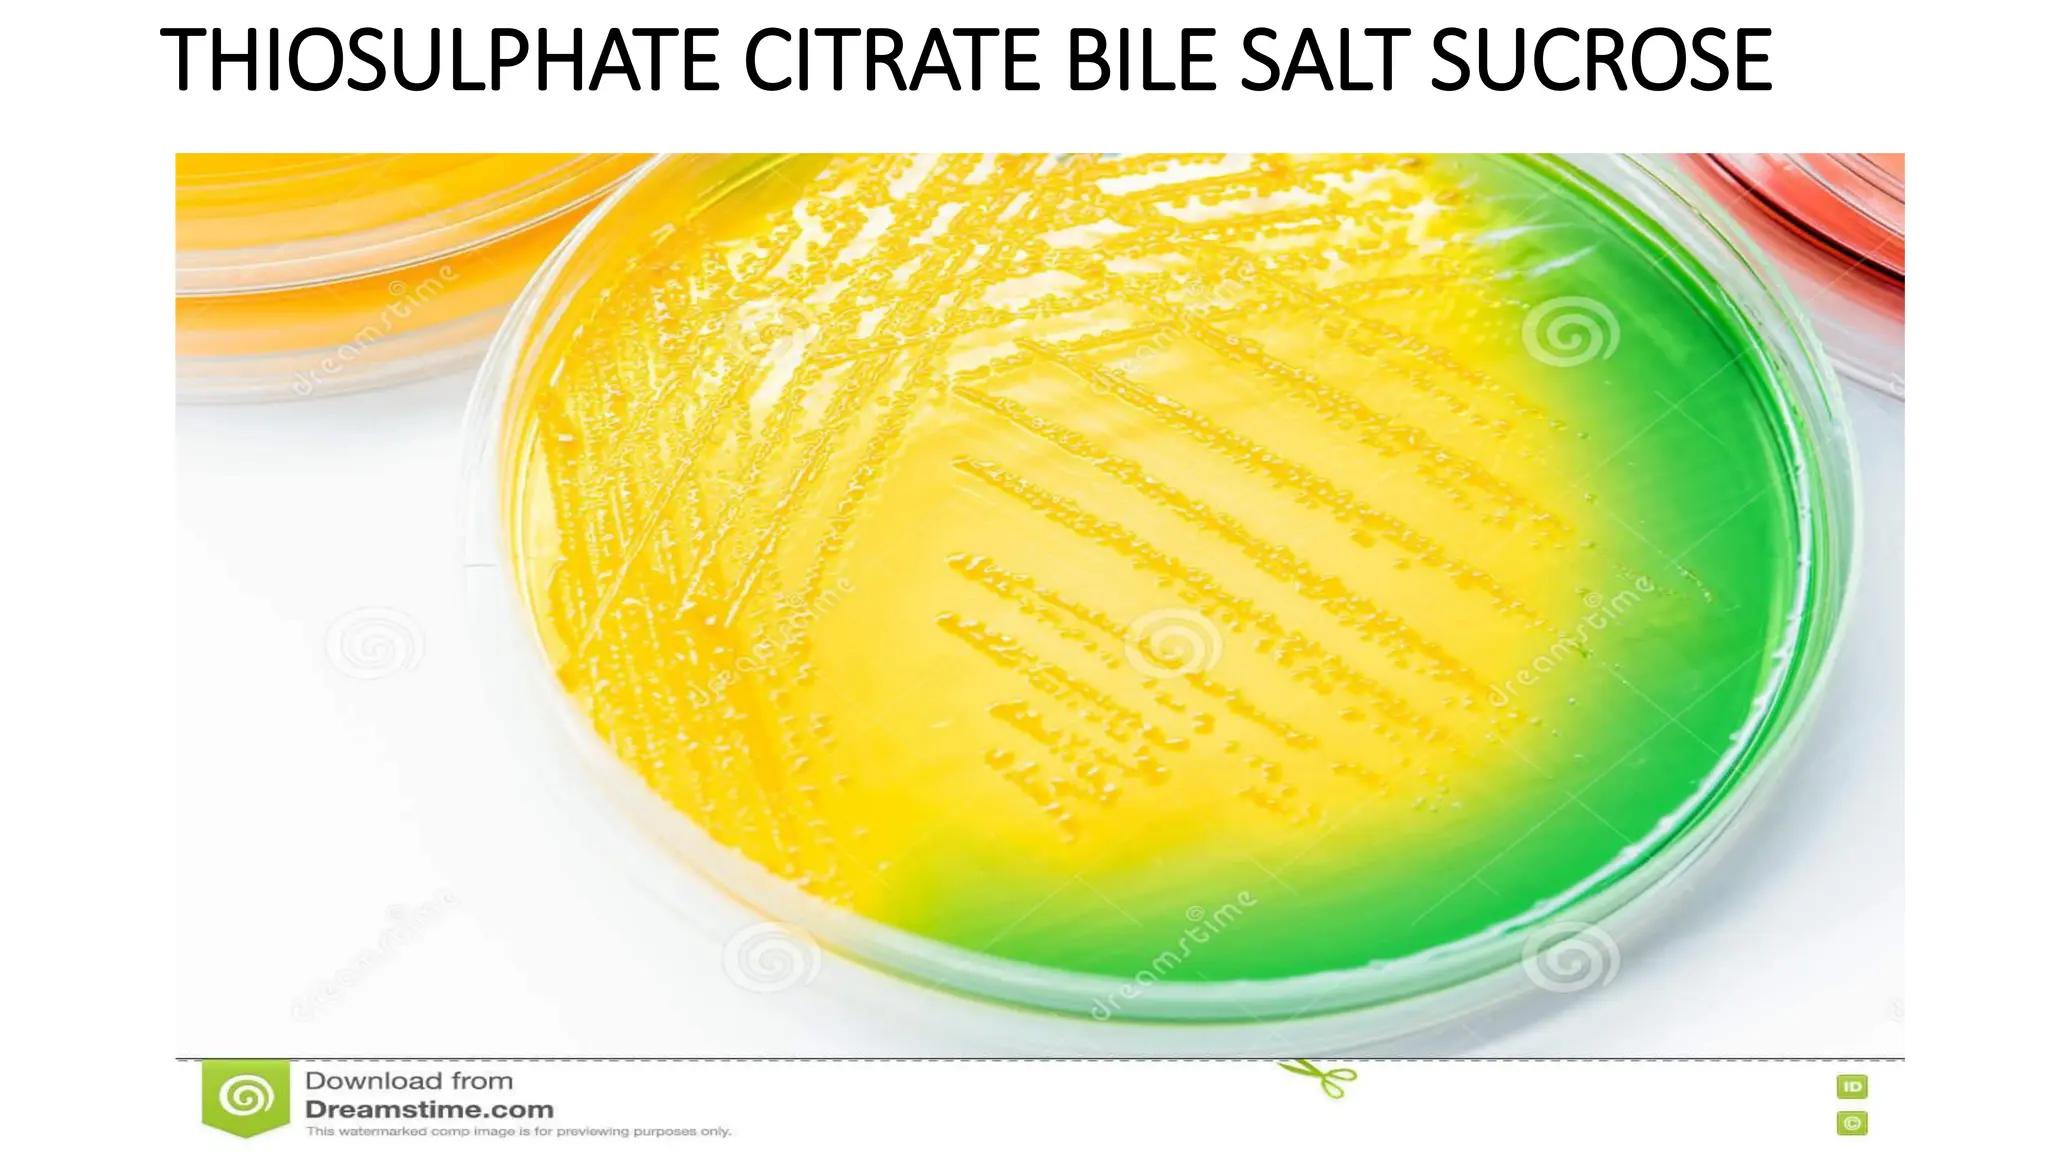
THIOSULPHATE CITRATE BILE SALT SUCROSE
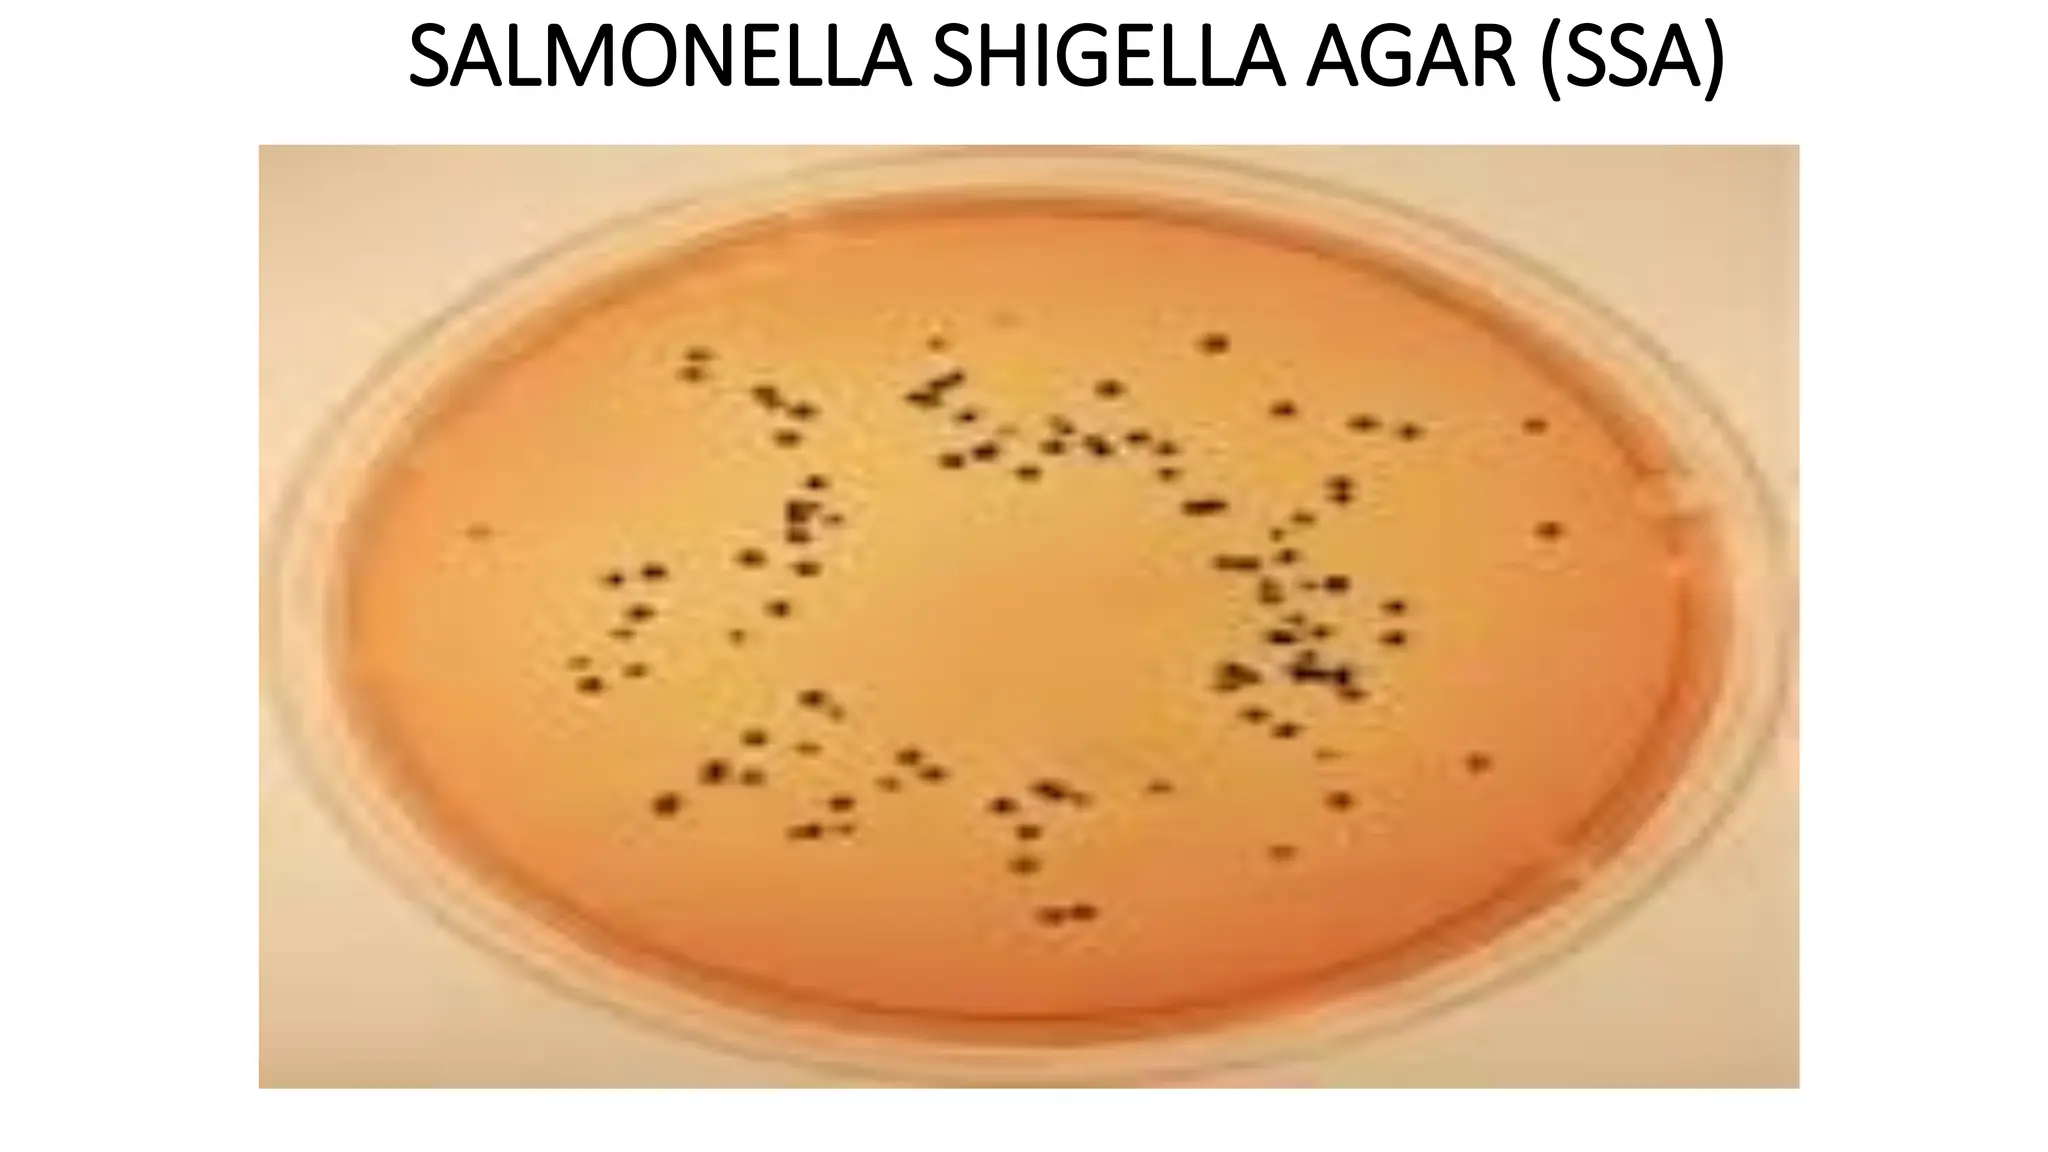
SALMONELLA SHIGELLA AGAR (SSA)
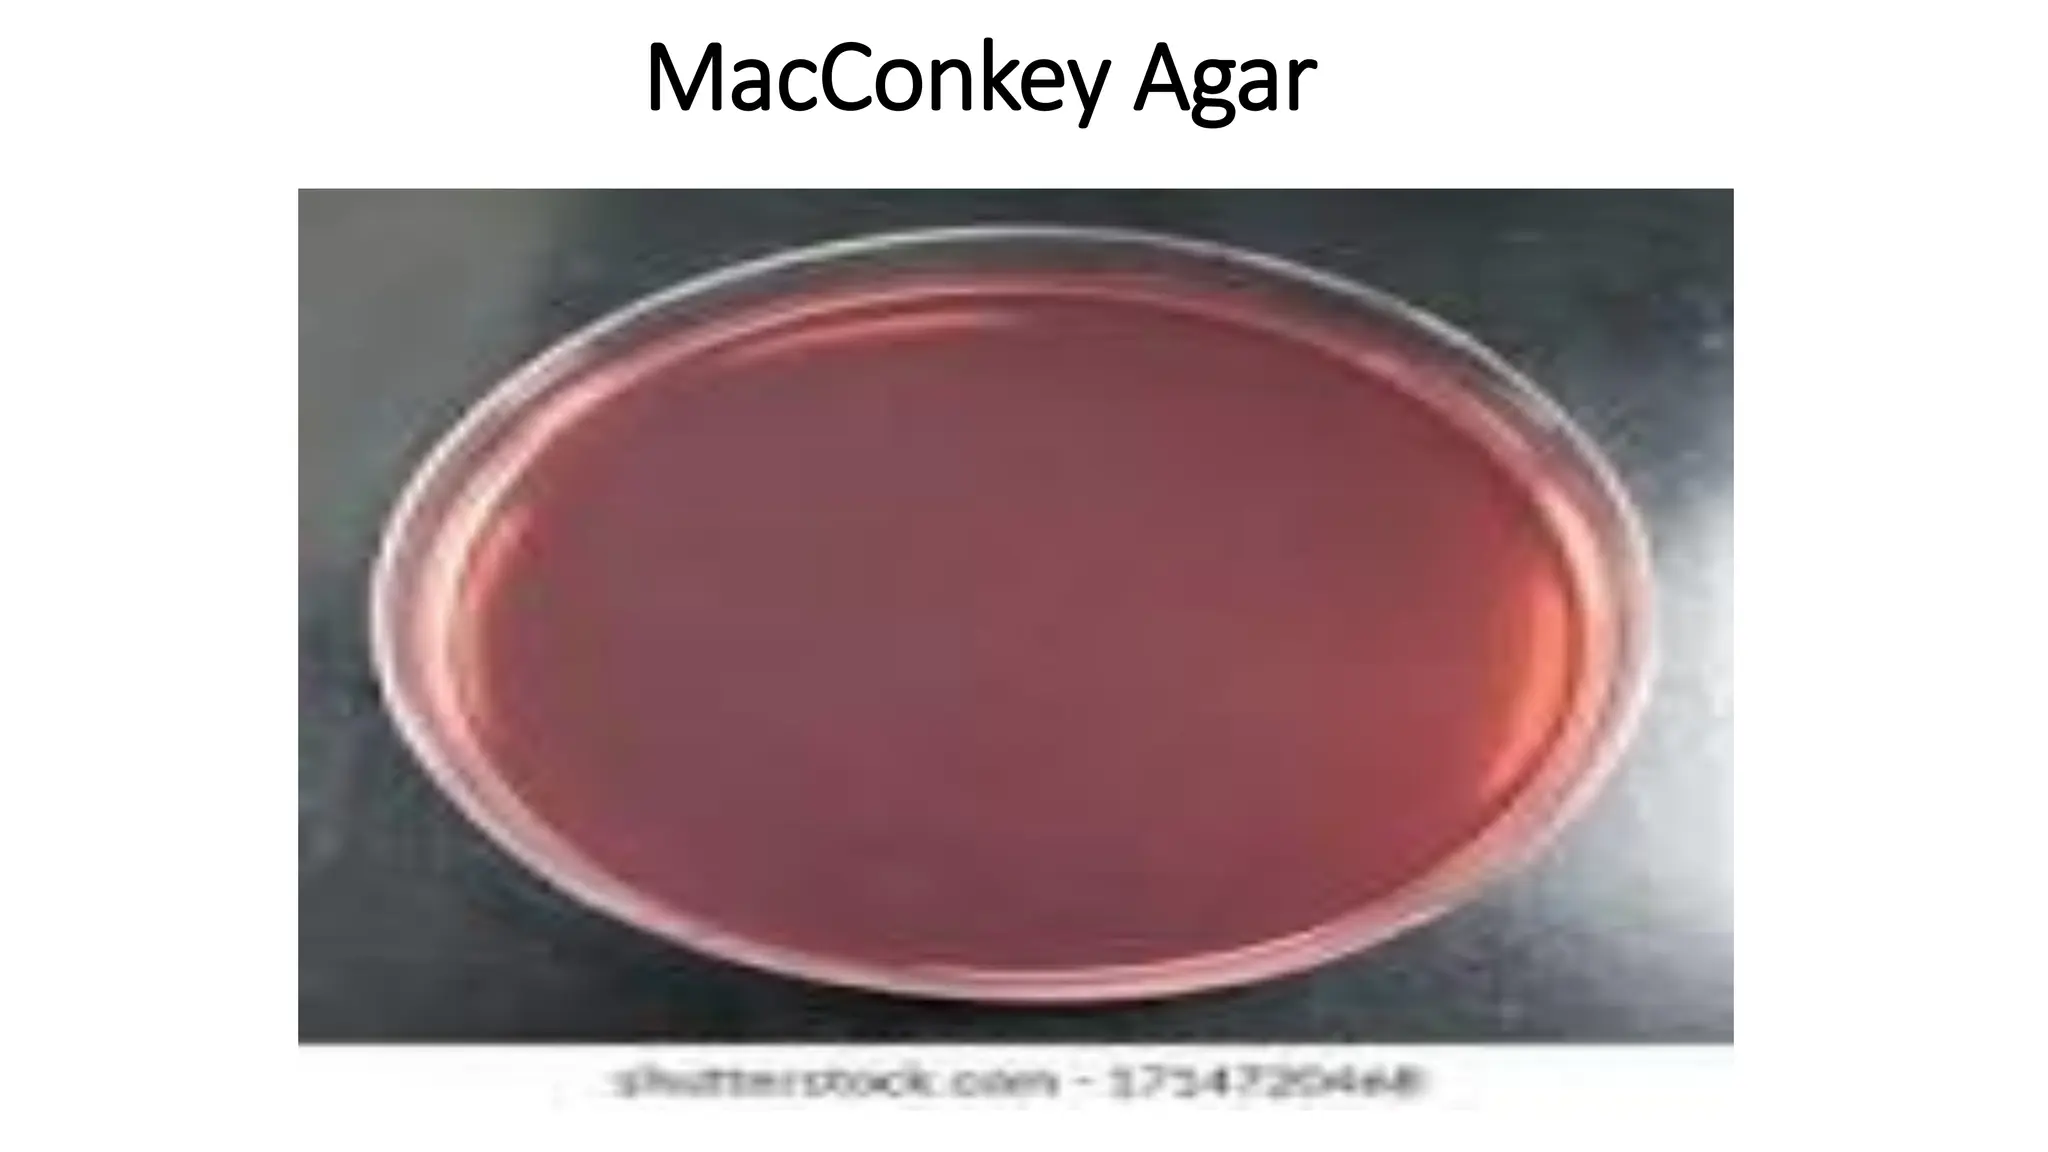
MacConkey Agar
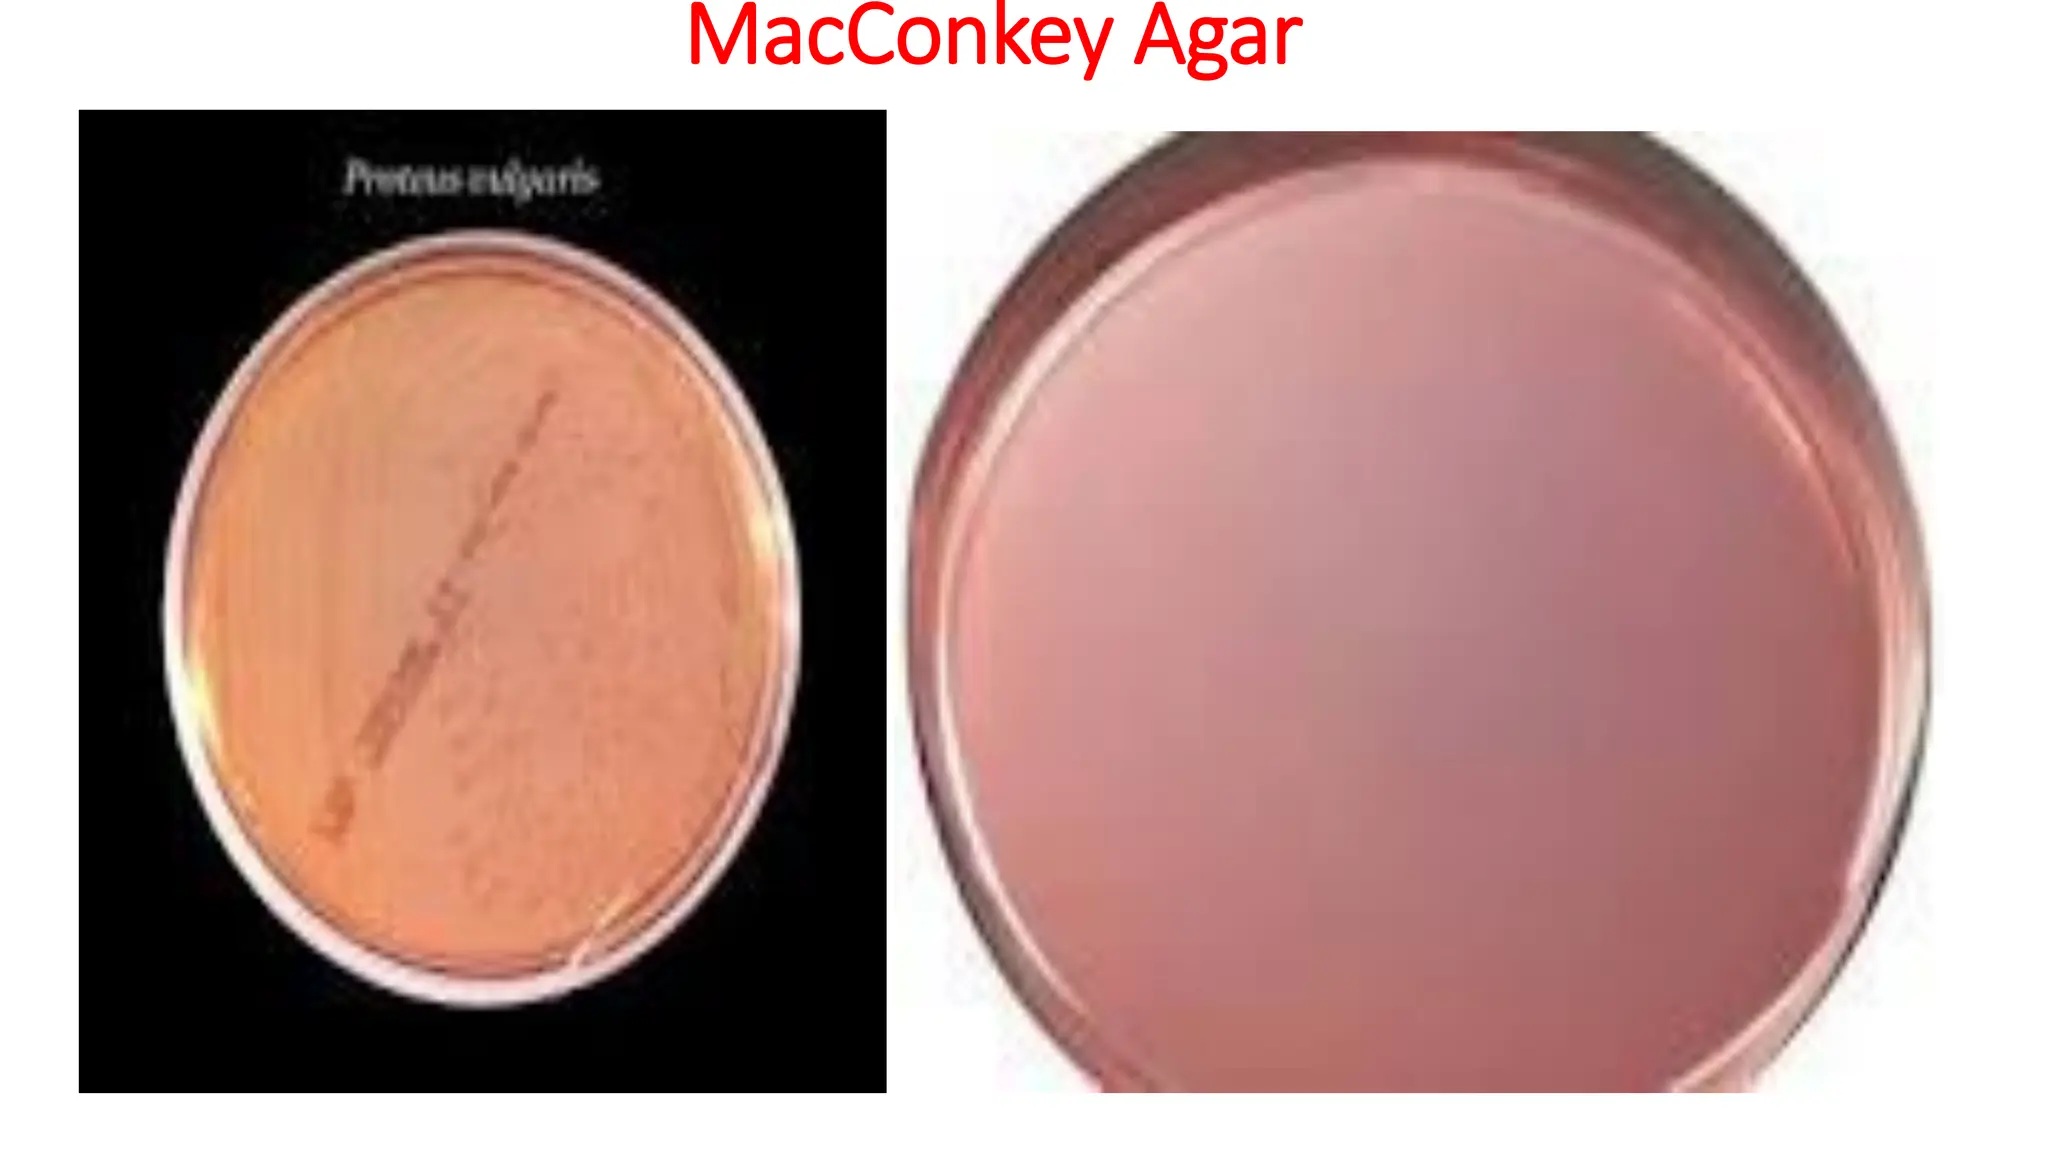
MacConkey Agar
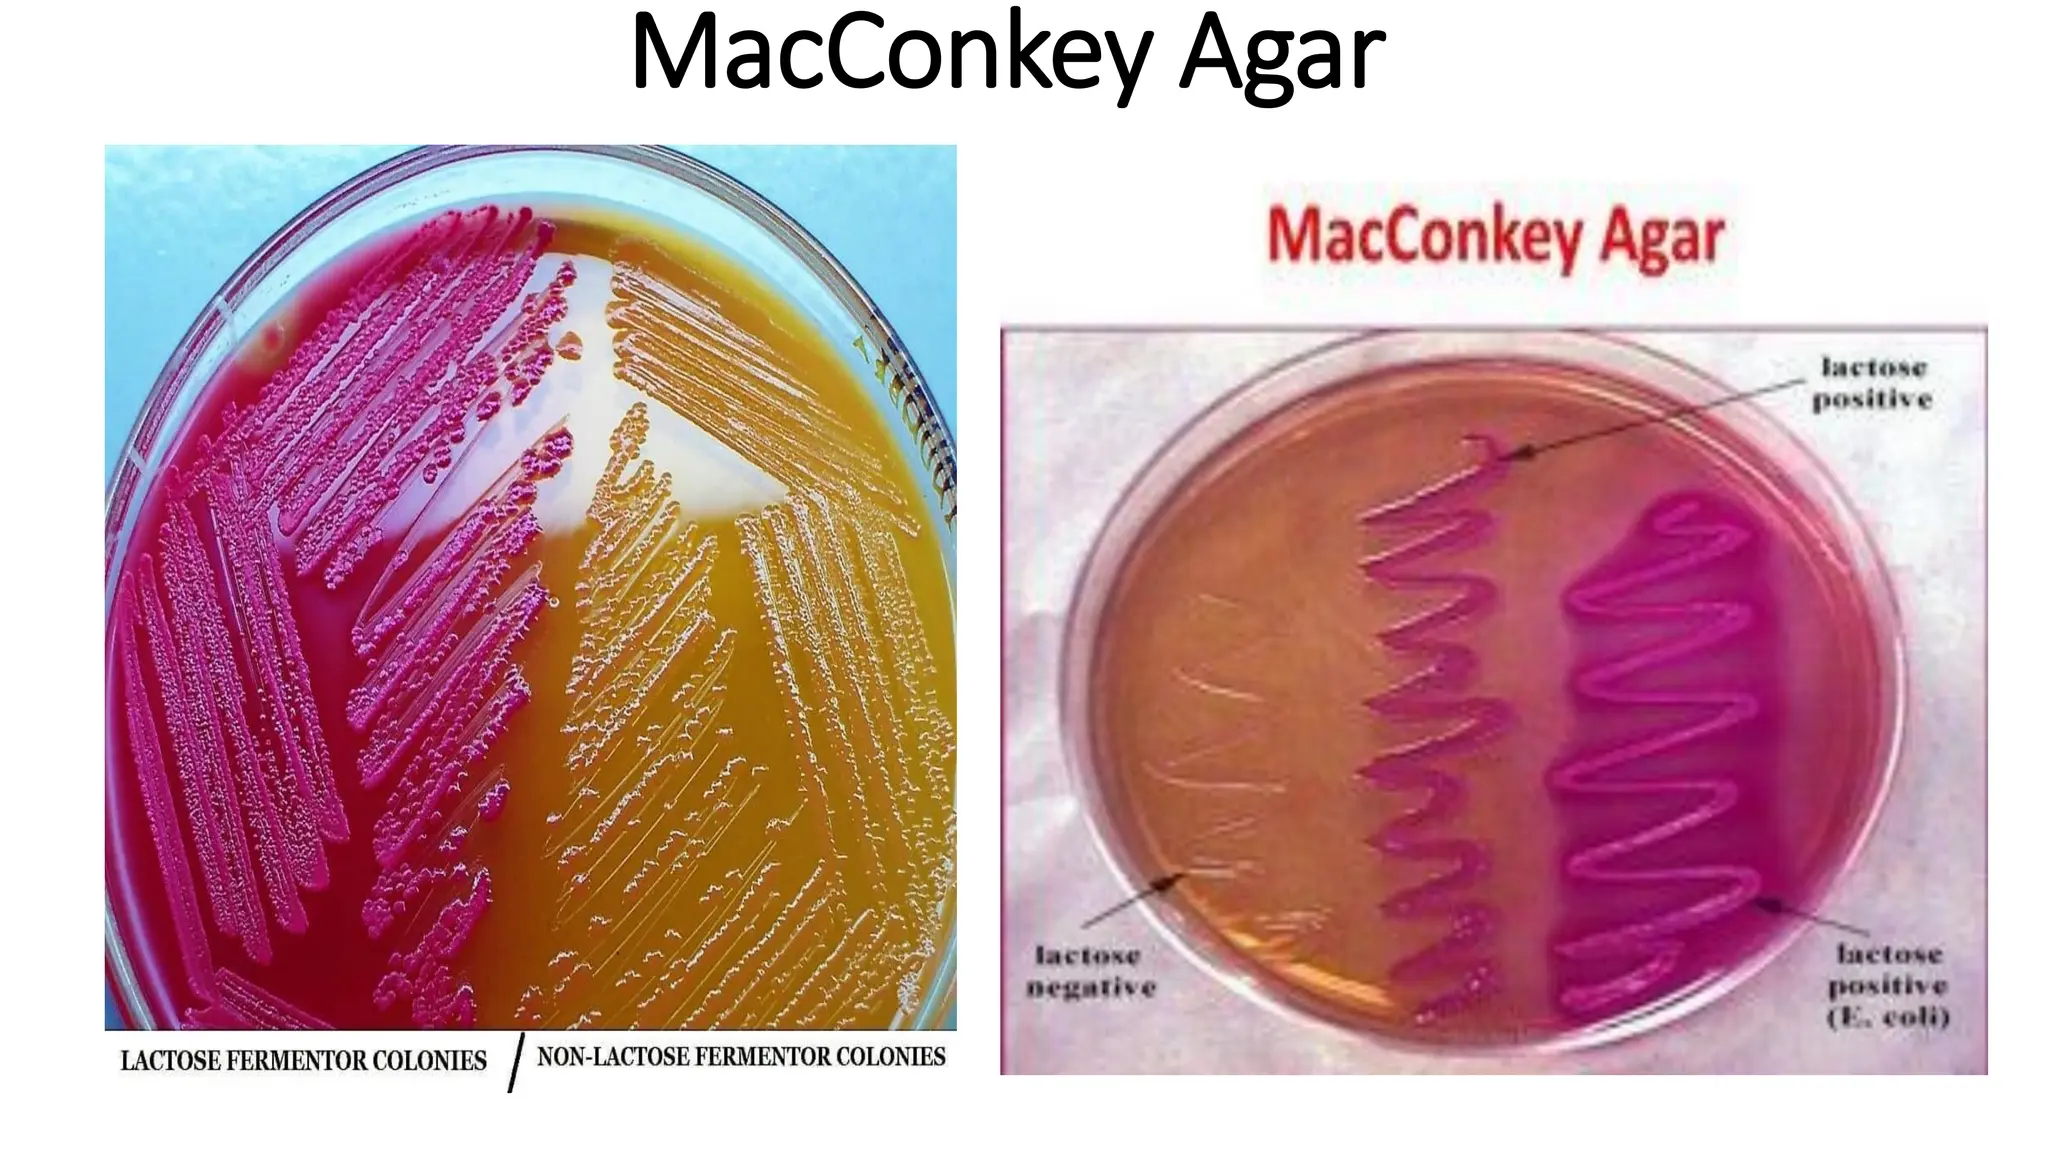
MacConkey Agar
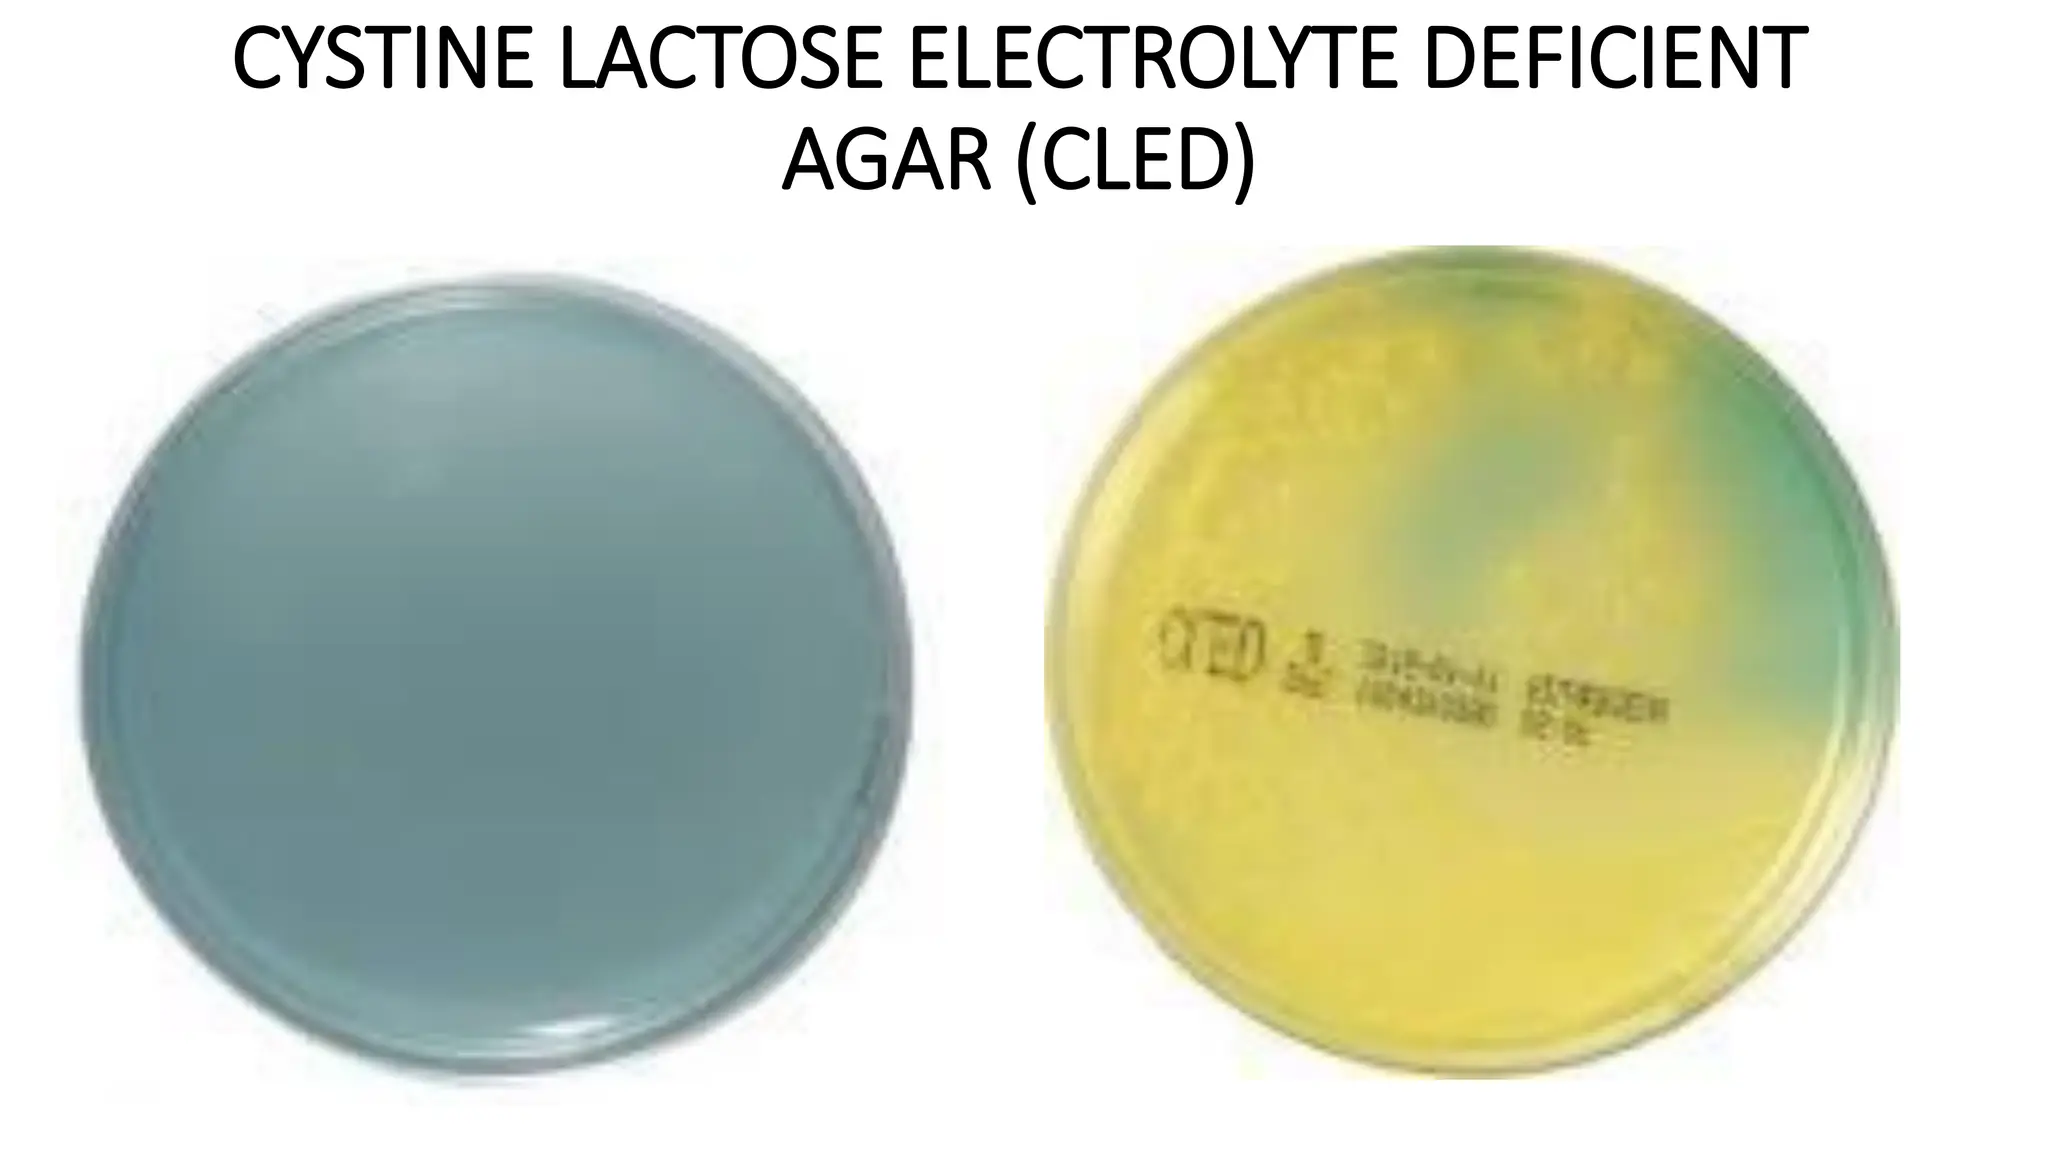
CYSTINE LACTOSE ELECTROLYTE DEFICIENT
AGAR (CLED)
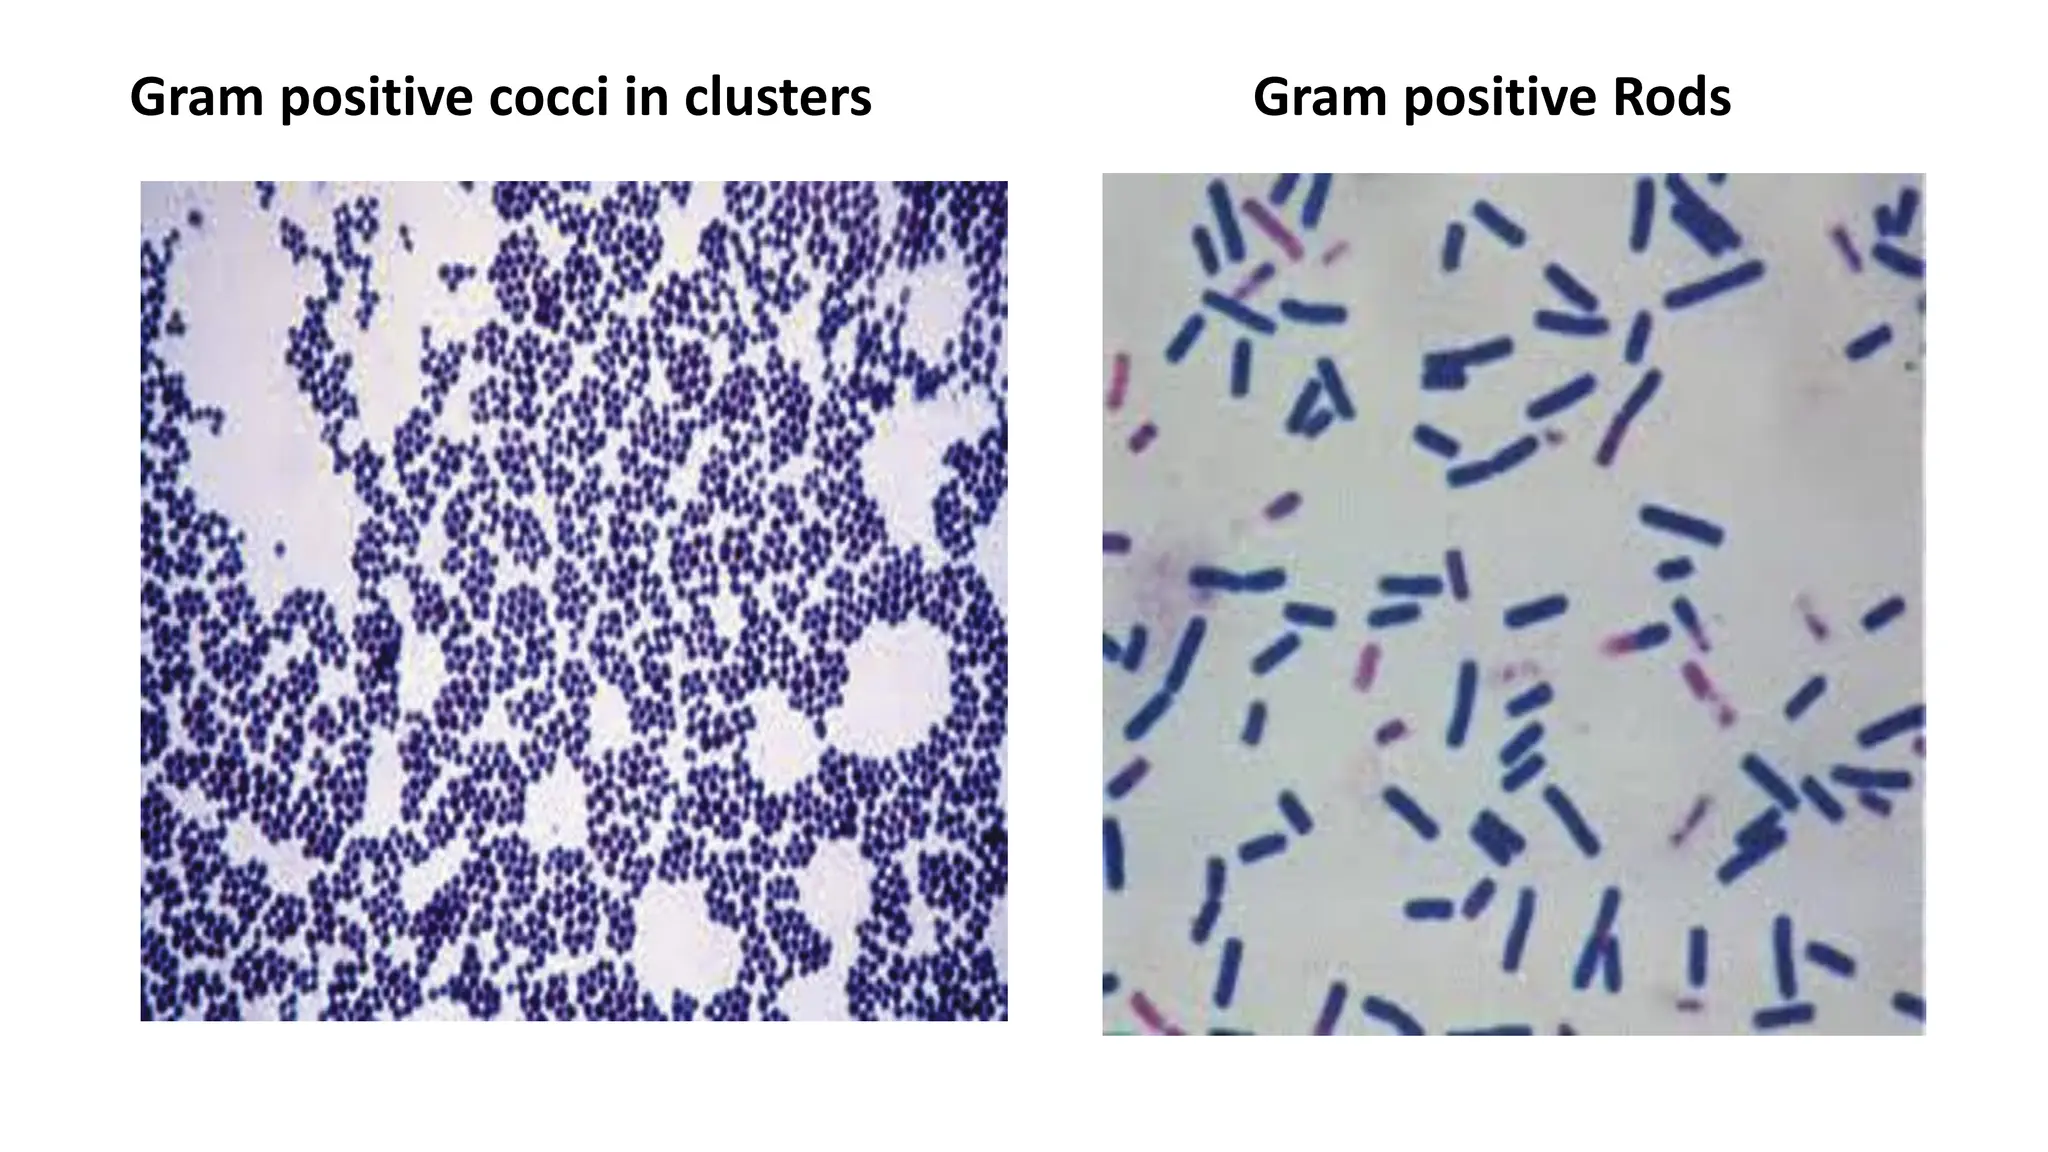
Gram positive cocci in clusters Gram positive Rods
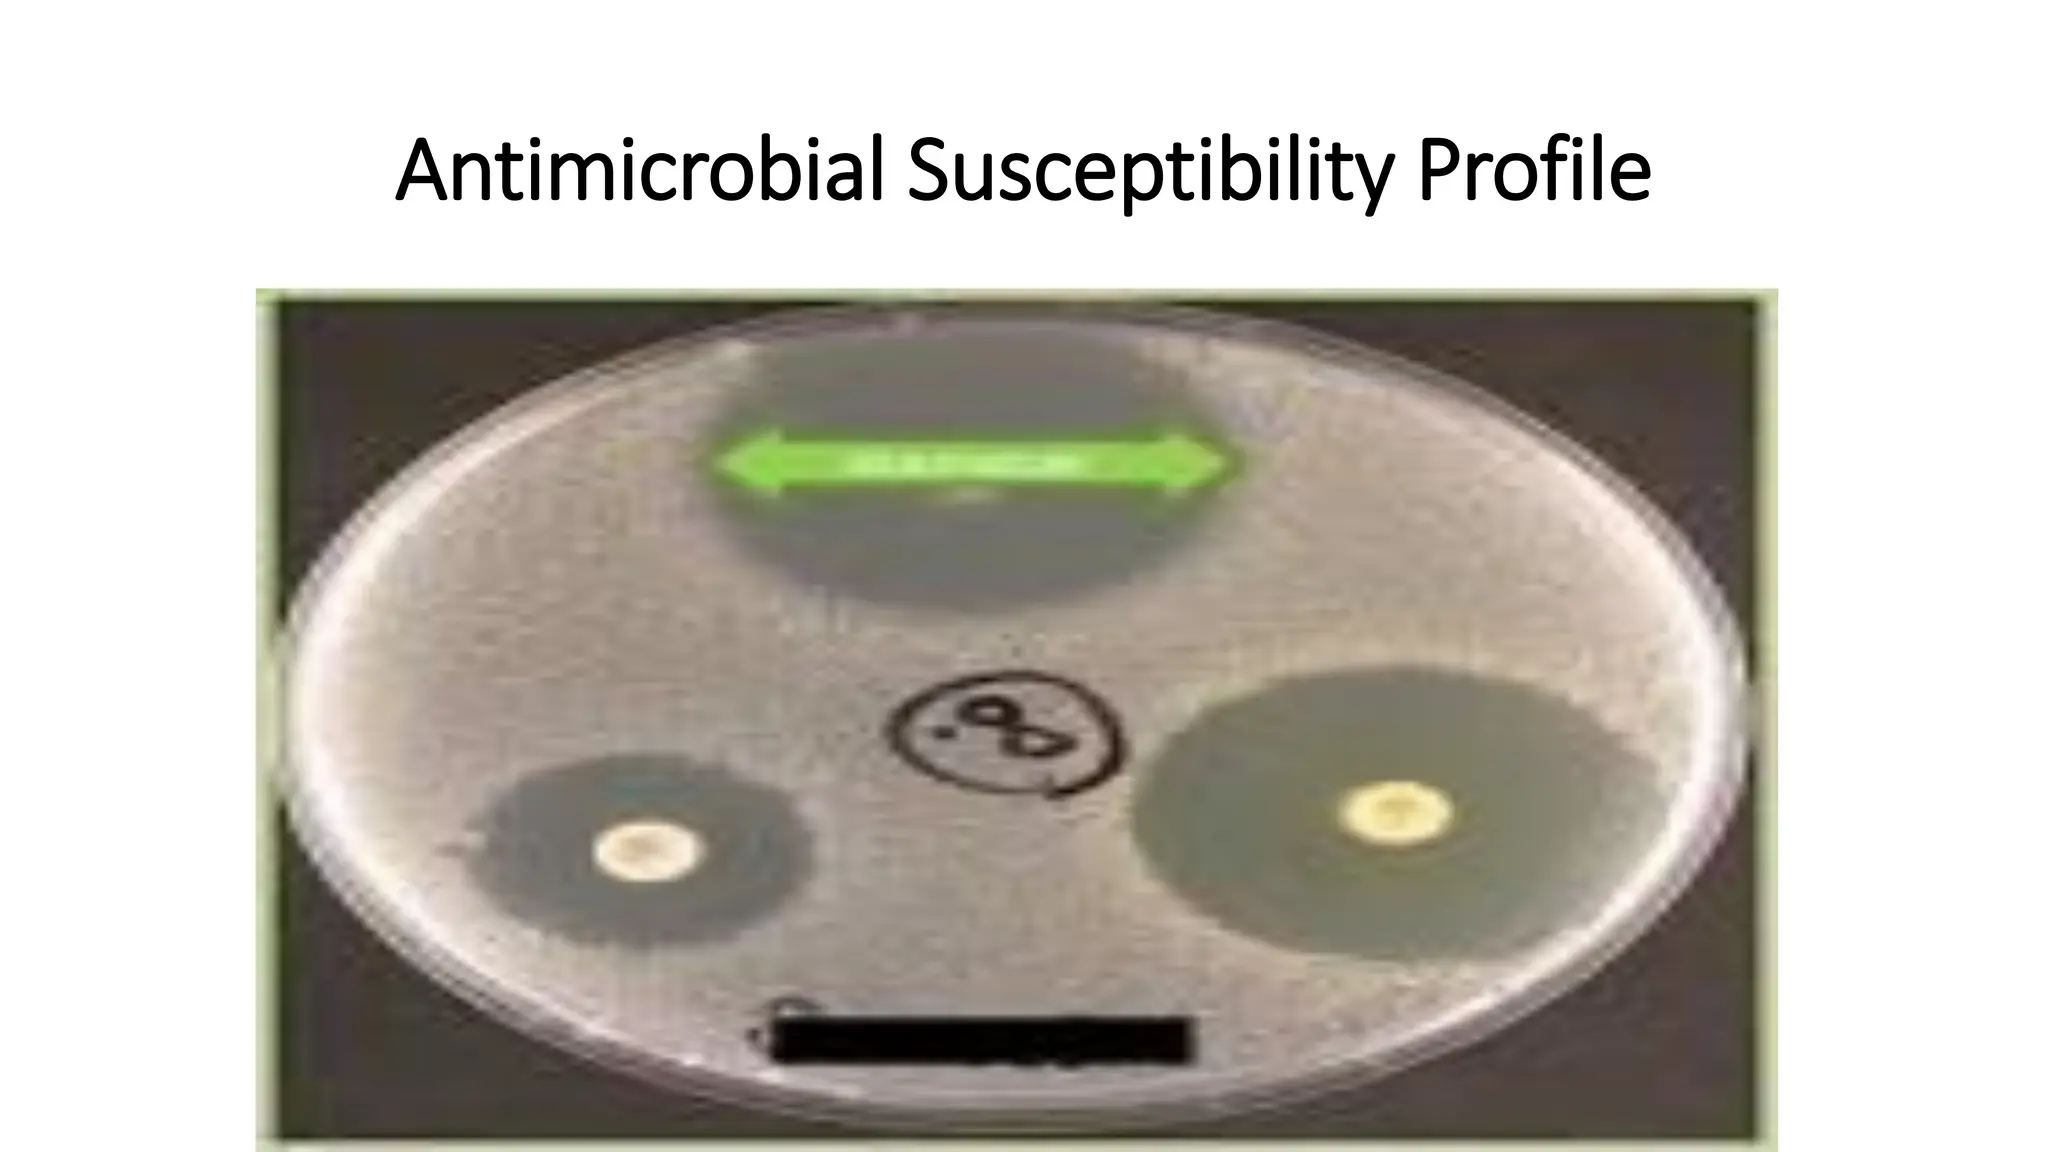
Antimicrobial Susceptibility Profile
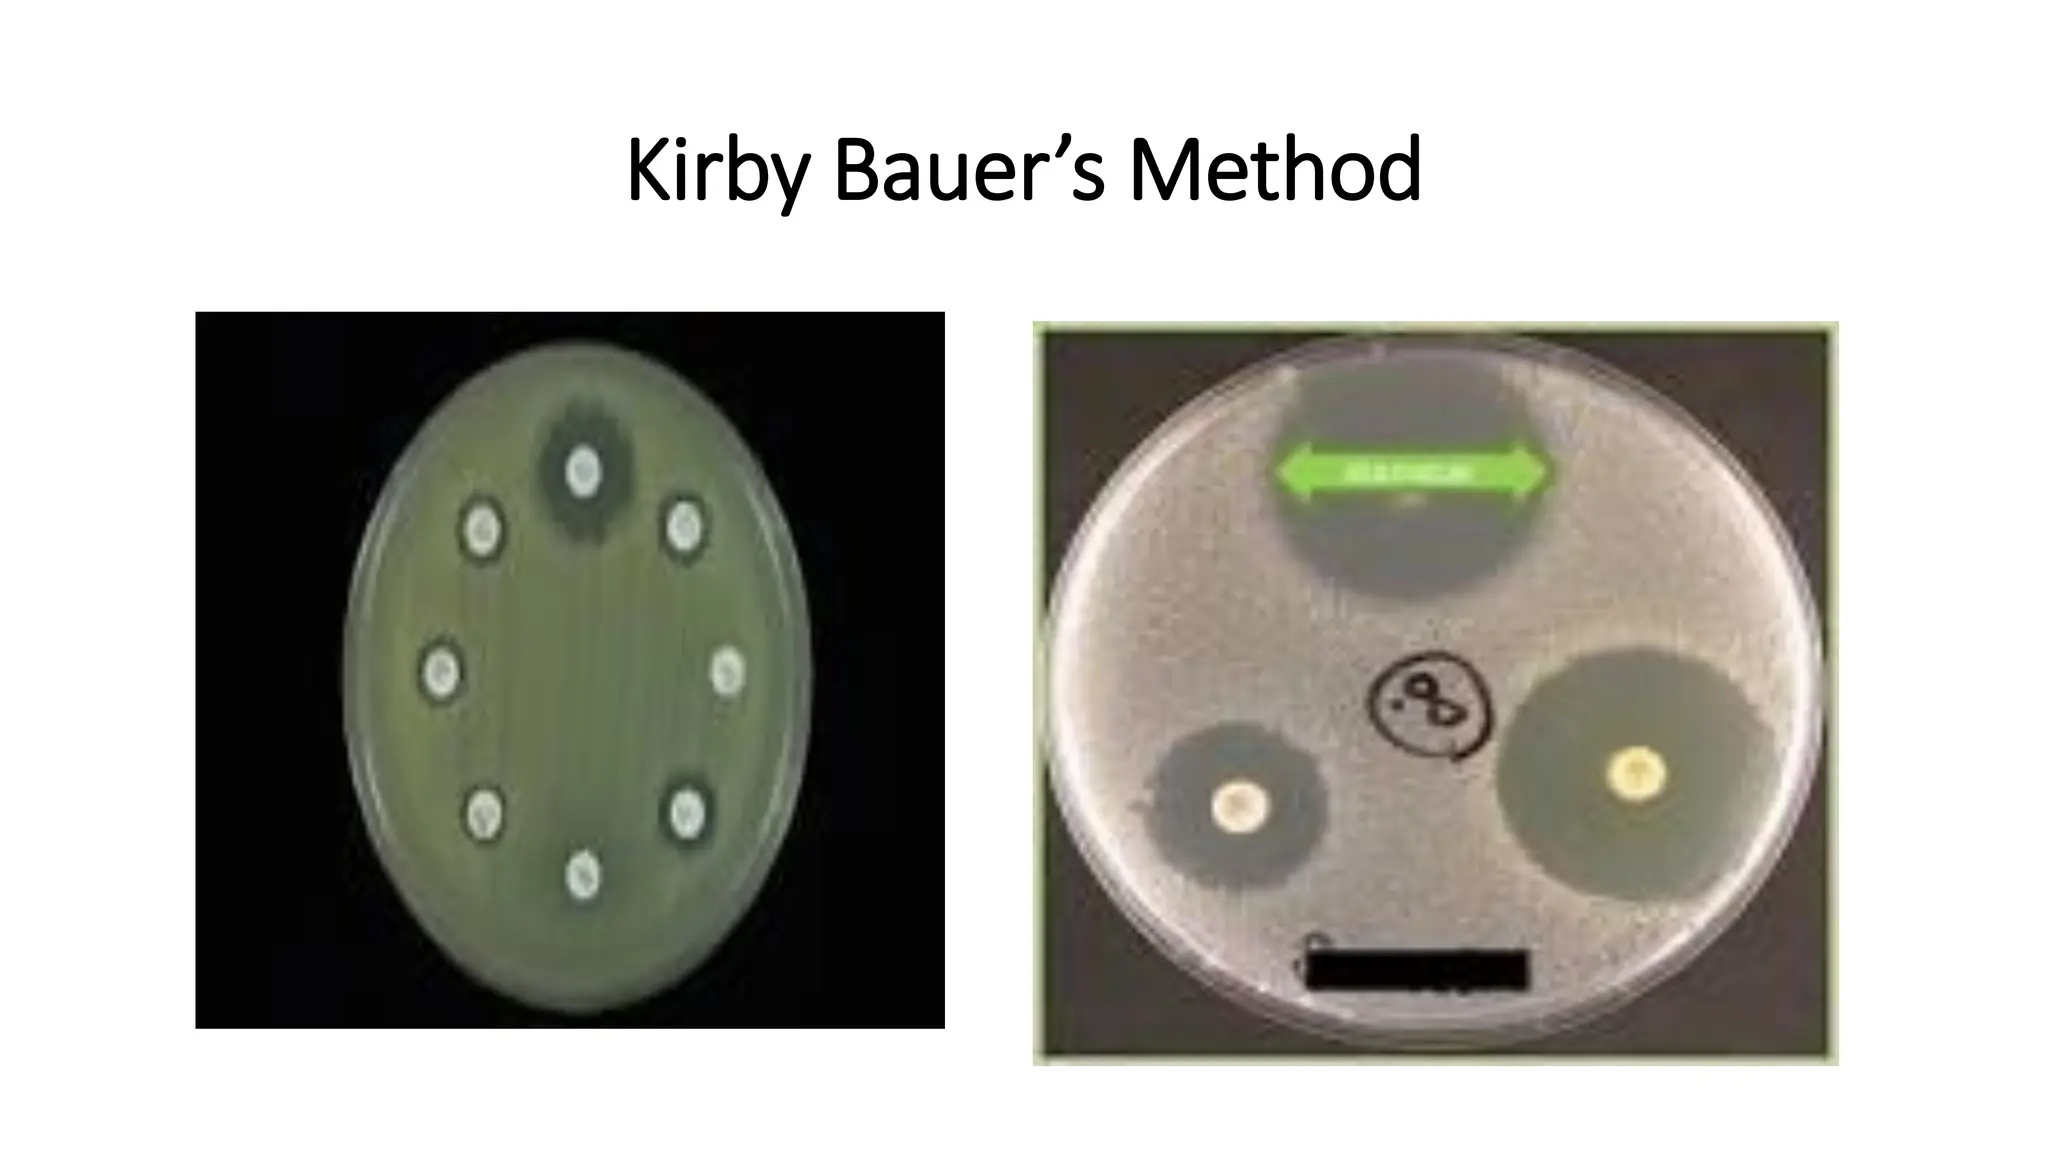
Kirby Bauer’s Method
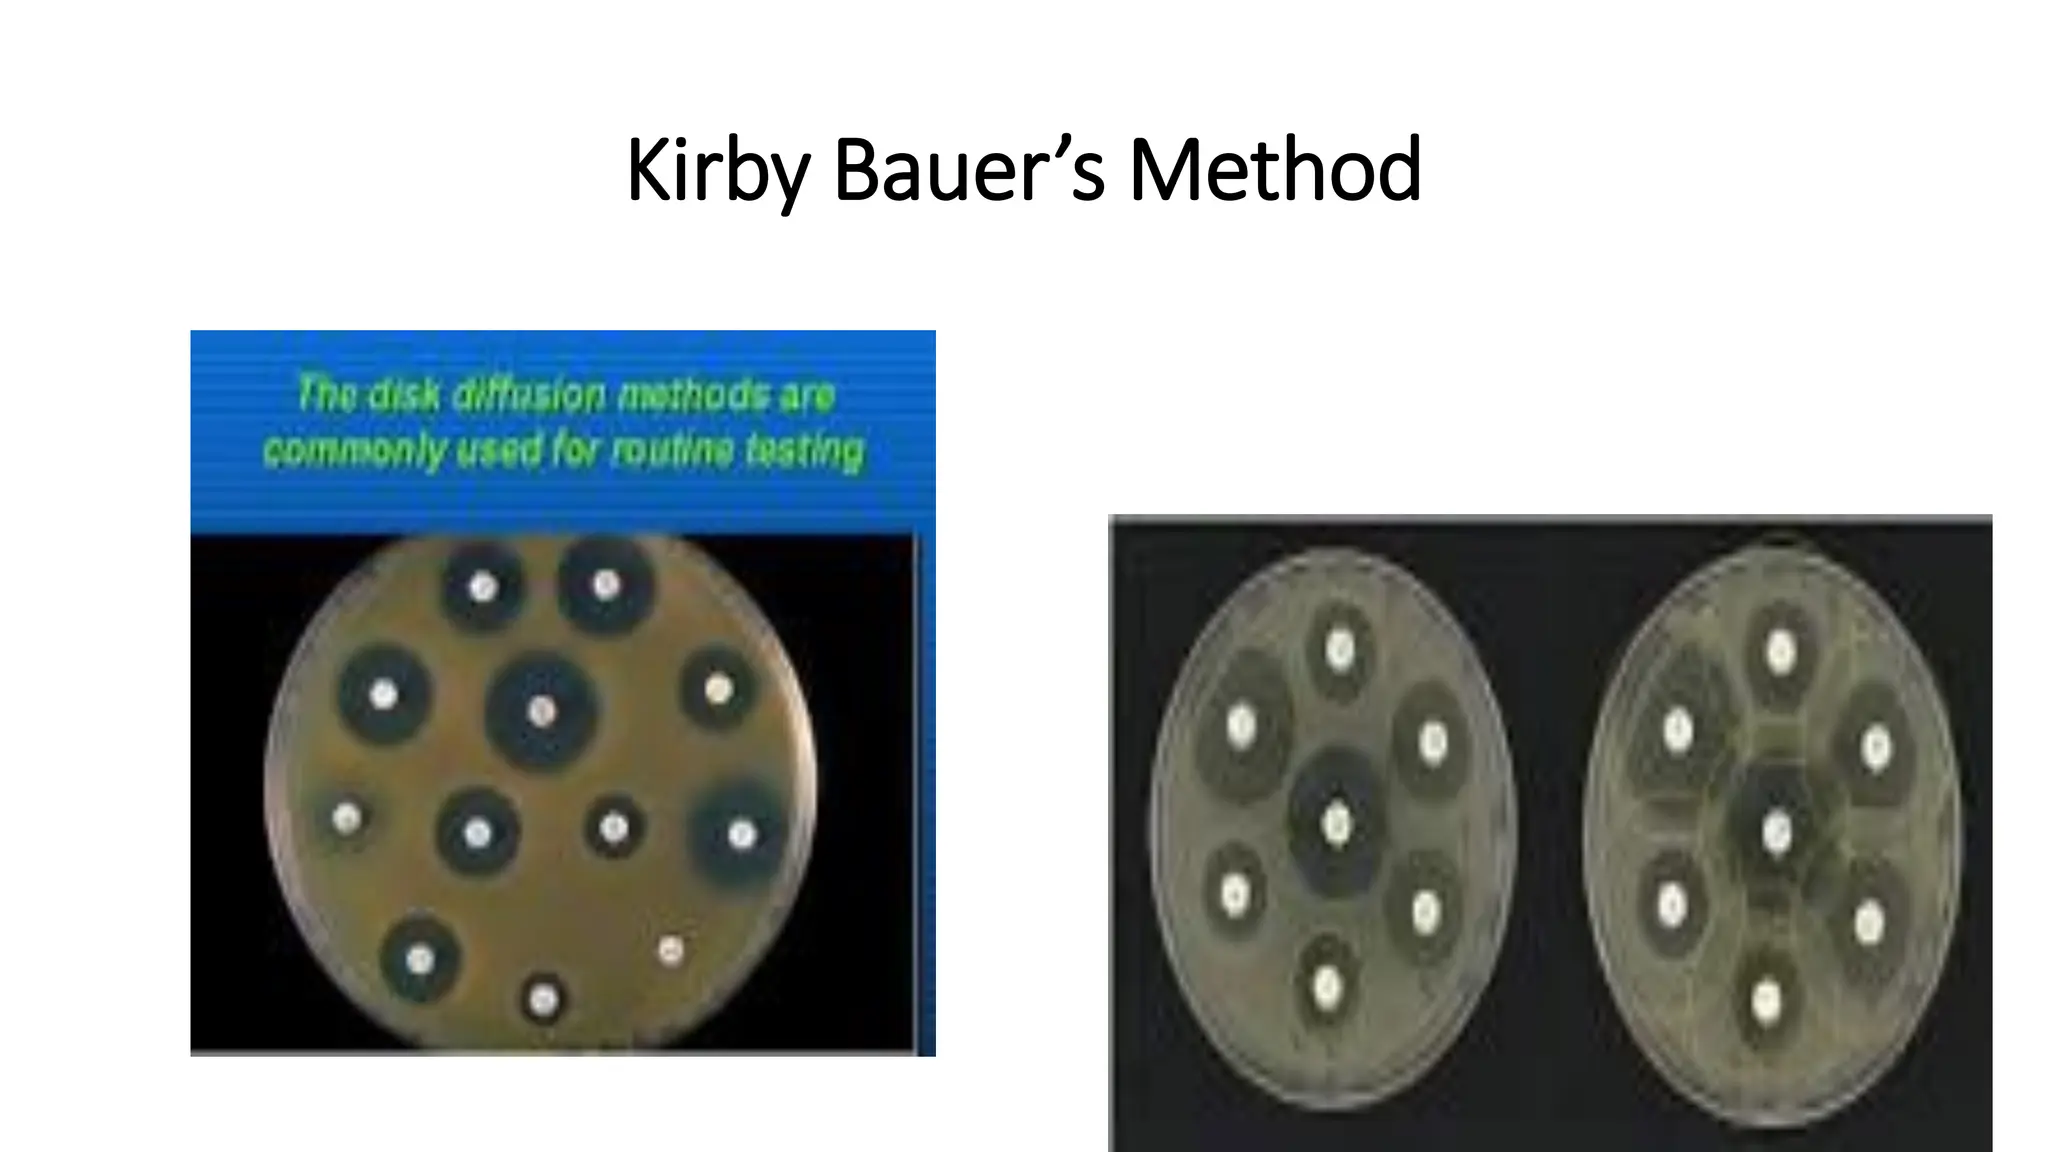
Kirby Bauer’s Method

The document outlines common viruses, fungi, bacteria, and parasites along with the diseases they cause. It details clinical microbiology tools and equipment, including microscopes, autoclaves, and incubators, as well as various sterilization methods. Additionally, it discusses different media types for bacterial culture and emphasizes the importance of sterilization and disinfection in clinical settings.